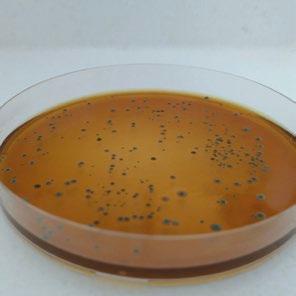

LOS DESAFÍOS DEL STREPTOCOCCUS SUIS
SEROTIPO 9 EN LA PRÁCTICA

ESPECIAL EVALUACIÓN DE RIESGOS
Prevención y control de la transmisión de enfermedades a través del alimento
Evaluación del riesgo de introducción de un patógeno a una granja y su impacto económico
p. 14
Nuevos Horizontes



Nutrigenómica Porcina
Fundamentos Esenciales



Fibra Dietética en Cerdos y Micotoxinas
Visión a la Transformación en los próximos años
Avances Claves



Impacto de densidad y CM de comederos en la etapa de engorde
Alternativas Sin Antibióticos
Nutrición de precisión


Clima y Nutrición
Restricción Alimentaria en Cerdas Gestantes y Enzimas Exógenas

Subproductos Agroindustriales en la Dieta Porcina
¡Súmate a PIGTIONARY! porcinews.com/abc/abc-nutricion
RESILIENCIA, RESISTENCIA, Y TOLERANCIA, ¿DE QUÉ
ESTAMOS HABLANDO?
El rendimiento productivo de un animal en una granja depende, sí, de su potencial genético, pero sobre todo de los retos, entre otros, sanitarios, nutricionales, y/o medio ambientales a los que los enfrentamos.
Si estas condiciones no son las adecuadas, un animal con mayor resiliencia tendrá la capacidad de expresar mejor su potencial genético, y mantener los indicadores claves de rendimiento (ICP)
La resiliencia en el sentido estricto se define como la capacidad de un animal para mantener los ICP durante la infección, o para retornar a ellos, independientemente del reto infeccioso al que sea sometido.
Y de manera general, se define como la capacidad de reconocer el cambio y anticipar futuras alteraciones a través de su potencial de adaptación, o sea que es más robusto. Esto gracias a su resistencia o tolerancia, o a una combinación de ambas.
Un animal con poca o nula resistencia y tolerancia no puede eliminar a un patógeno (resistencia), ni al daño causado por éste (tolerancia), así que, si no es tratado y/o vacunado efectivamente, morirá.
Ahora bien, si muchos animales de un grupo son resistentes, hay pocas posibilidades de una epidemia.
Sin embargo, hasta que el sistema inmune no haya eliminado al patógeno, uno o varios animales permanecerán infecciosos. La diferencia es que los animales resistentes eliminan al patógeno rápidamente, pero los tolerantes seguirán contagiosos.
Por lo tanto, la resiliencia de la piara es mucho más importante que el promedio de los valores de resiliencia individuales.
Con el desarrollo de las tecnologías genómicas y fenotípicas para alto rendimiento, existen oportunidades interesantes para que sigamos incorporando animales más robustos a nuestra piara.
EDITOR AGRINEWS LLC
PUBLICIDAD
Luis Carrasco +34 605 09 05 13 lc@agrinews.es
Félix Muñoz +34 618 18 00 16 felix@mediatarsis.com
COMITÉ TÉCNICO
Laura Batista
Roberto M.C. Guedes
REDACCIÓN
Noelia Ammendolea
Óscar Cáceres
Maria Emilia Andreani
ATENCIÓN AL CLIENTE secretaria@grupoagrinews.com
ADMINISTRACIÓN
Mercè Soler admin@agrinews.es
Mientras tanto, no olvidemos que la salud, la vigilancia epidemiológica, la bioseguridad, las instalaciones, y el manejo apropiado gracias a un equipo bien capacitado, siguen siendo muy importantes para lograr una producción óptima.

Precio de suscripción anual: 90 USD info@grupoagrinews.com porcinews.com grupoagrinews.com
Revista de distribución gratuita
DIRIGIDA A VETERINARIOS Y TÉCNICOS
Depósito Legal Porcinews B17989-2015
Laura Batista Batista & Asociados
ISSN (Revista impresa) 2696-8169
ISSN (Revista digital) 2696-8177
Revista trimestral
La dirección de la revista no se hace responsable de las opiniones de los autores. Todos los derechos reservados.
Imágenes: Noun Project / Freepik/Dreamstime
porciNews A.Latina Junio 2024 1

América Latina porciNews
CONTENIDOS
04

Efectos del medioambiente en el bienestar del porcino
Verónica Jimenez Grez
MV MSc Etología y Bienestar Animal
Uno de los factores clave que influyen en el bienestar porcino es el medio ambiente en el que viven los animales.
ESPECIAL EVALUACIÓN DE RIESGOS
24

14



Los desafíos del Streptococcus suis serotipo 9 en la práctica
Carlos Eduardo
Real Pereira1, Lucas Fernando dos Santos2, José Lúcio dos Santos2
1 Universidade Federal de Viçosa, UFV, Viçosa-MG,
2 Microbiologia Veterinária Especial, Microvet, Viçosa-MG
Streptococcus suis (S. suis) serotipo 9 ha surgido como un desafío apremiante en la porcicultura brasileña, especialmente en el sur del país, provocando pérdidas sustanciales en la industria.
Prevención y control de la transmisión de enfermedades a través del alimento
Pedro E. Urriola
Profesor Asociado en el Departamento de Ciencias Animales de la Universidad de Minnesota
El análisis de riesgos es una herramienta esencial que posibilita la evaluación cualitativa y cuantitativa del riesgo de propagación de una enfermedad en situaciones predefinidas.
32

Evaluación del riesgo de introducción de un patógeno a una granja y su impacto económico
Laura Batista
Batista & Asociados, Asesora para el sector porcino mundial, México/Canadá
Una comprensión adecuada de la dinámica de transmisión y de los factores de riesgo para la propagación epidémica de estos virus, es la clave para diseñar estrategias de prevención y control eficaces.
porcinews.com
2 porciNews A.Latina Junio 2024
40
Estrategias de manejo durante la gestación y lactancia en genéticas modernas
Artículo traducido y adaptado de: Bortolozzo, F.P.; Zanin, G.P.; Ulguim, R.d.R.; Mellagi, A.P.G. Managing Reproduction in Hyperprolific Sow Herds
Comprender los mecanismos fisiológicos responsables del desarrollo reproductivo y productivo de los genotipos de cerdas modernos ayudará a crear o adaptar recomendaciones de manejo para la granja.
50
Placentación: análisis del impacto en el peso fetal –Parte II
Leticia P. Moreira, Saffir D. Fernandes, João Vitor L. Ferreira, Abner Shinkawa, Dayanne K. O. Pires, Isadora
M. S. de Oliveira, Stephanny R. Rainha, Túlio C. C. de Alkmim, José Andrés Nivia Riveros, Fernanda R. C. L. Almeida
Instituto de Ciências Biológicas da Universidade Federal de Minas Gerais
Las características de la placenta y la incidencia de la mortalidad predestete parecen estar asociadas con el peso del lechón al nacer
Efectos benéficos de un probiótico en lechones 64

Constanza Stoppani Ingeniera agrónoma (MSc)
La creciente restricción en el uso de antibióticos promotores de crecimiento (APC) con el fin de atenuar los efectos negativos del estrés posdestete, ha llevado a la búsqueda de alternativas.
Efecto de la actividad probiótica del hidrolizado Saccharomyces cerevisiae en los parámetros productivos de cerdas lactantes
Vicente Bryan Solís-Véliz1, Manuel Octavio RiveraCedeño1, Ernesto Antonio Hurtado2* y Mario Andrés Carreño-Arteaga2
1Escuela Superior Politécnica Agropecuaria de Manabí, Posgrado de Zootecnia. Calceta, Manabí, Ecuador.
2Escuela Superior Politécnica Agropecuaria de Manabí, carrera de Medicina Veterinaria. Calceta, Manabí, Ecuador.
Los prebióticos y probióticos a base de levadura, se han considerado una alternativa de interés debido a su potencial para modular positivamente la microflora intestinal, lo que puede conducir a una mejor inmunidad, digestión y absorción de nutrientes y rendimiento del crecimiento.
El uso de grasas oxidadas en la alimentación porcina: el hato reproductor (Parte 2/3) 56
Gerardo Ordaz Ochoa, María Alejandra Pérez Alvarado, Luis Humberto López Hernández Centro Nacional de Investigación Disciplinaria en Fisiología y Mejoramiento Animal, INIFAP, México
El creciente uso de grasas oxidadas en la dieta del hato reproductor con el supuesto objetivo de reducir costos en la alimentación genera incertidumbre por sus repercusiones en la salud y la reproducción.

70
3 porciNews A.Latina Junio 2024
EFECTOS DEL MEDIOAMBIENTE EN EL BIENESTAR DEL PORCINO
Verónica Jimenez Grez MV MSc Etología y Bienestar Animal

El bienestar animal es un aspecto fundamental por considerar en la producción animal moderna. No solo es una responsabilidad ética y moral, sino que también tiene implicaciones directas en la salud y productividad de los cerdos.
Uno de los factores clave que influyen en el bienestar porcino es el medio ambiente en el que viven los animales. Este se puede definir como todo aquello que rodea al animal, es decir, el entorno donde se encuentra.

Desde parámetros ambientales como la temperatura, humedad, calidad del aire, ventilación, hasta infraestructura y espacio disponible por animal. Cada aspecto del entorno puede tener un impacto significativo en la calidad de vida de los cerdos.
En este artículo, exploraremos los efectos del ambiente sobre el bienestar porcino y cómo podemos mejorar estas condiciones para asegurar su bienestar.
porciNews A. Latina Junio 2024 | Efectos del medioambiente en el bienestar del porcino bienestar 4
El entorno físico corresponde a uno de los 5 dominios del bienestar animal, Temple Grandin describe en su paper del 2022 titulado: Practical Application of the Five Domains Animal Welfare Framework for Supply Food Animal Chain Managers, que abarca tanto el ambiente en una instalación como el entorno en el alojamiento.

ACCEDER AL PAPER
Las fallas en el manejo de animales pueden estar asociados a deficiencias en el entorno, como suelos resbaladizos o errores de diseño en las instalaciones de manejo (Grandin, T. 2021)
Para cada etapa productiva debemos proveerles las necesidades según los requerimientos específicos de cada una de estas.
1
FACTORES TÉRMICOS
El ambiente térmico abarca: radiación solar temperatura ambiental humedad relativa del aire velocidad del viento (Falco, 1997; Baêta y Souza, 2010).
Los cerdos son animales homeotermos y endotermos.
Homeotermos significa que mantienen su temperatura corporal relativamente constante;
Endotermos significa que utilizan el calor producido por su propio metabolismo para mantener su temperatura corporal constante (Manteca, 2009).
Bond y Kelly (1960) describen el medioambiente en 3 factores:
1
2
“termales o térmicos” se refieren a temperaturas del aire, humedad relativa, corrientes de aire, radiación, etc
“físicos” se refieren a aspectos como espacio, luz, sonido, presión e instalaciones en general.
3
“sociales” son el tamaño de grupos, órdenes de dominancia y otros aspectos del comportamiento animal.
La especie porcina es especialmente susceptible a elevadas temperaturas debido a su limitada capacidad de sudoración (Kunavongkrit et al., 2005) ya que posee escasas glándulas sudoríparas (Dyce et al., 1997), alrededor de 30 por cm2 (Bracke y Spoolder, 2011).

El estrés por calor se produce cuando la temperatura medioambiental provoca un desequilibrio entre el calor producido por el animal y el disipado. Genera cuantiosas pérdidas económicas a los productores porcinos, consecuencia de los efectos adversos sobre el rendimiento y salud de los animales (Pardo, 2022).
El estrés térmico, una de las principales causas de pérdidas de producción en climas cálidos, se puede minimizar con el uso adecuado de equipos y procesos (Lin et al., 2006; Barbari et al., 2007) dentro de las instalaciones productivas, pudiendo así, en aquellas instalaciones automatizadas o manuales, implementar equipos que permitan controlar las temperaturas ambientales, condiciones de humedad y ventilación.
Los lechones recién nacidos son especialmente sensibles al frío (relacionado con el peso al nacimiento) menor peso, mayor son las necesidades térmicas.
En consecuencia, debemos proporcionar un ambiente térmicamente adecuado para ellos y uno diferente para la hembra.
Cada empleado asignado al sitio 1, en particular aquellos que trabajan en la sala de maternidad, debe estar bien capacitado acerca de la importancia de mantener una temperatura ambiental adecuada para asegurar el bienestar de las hembras y sus lechones.
Es esencial que la temperatura en esta área se mantenga dentro de la zona termoneutral para las hembras, que oscila entre los 18 y 22ºC.
Además, para satisfacer las necesidades térmicas de los lechones, es crucial suplementar calor utilizando lámparas calefactoras o paneles de calefacción en el piso, asegurando así que se alcance y mantenga la temperatura requerida para su óptimo desarrollo y salud.
Esta práctica no solo contribuye al confort de los animales, sino que también promueve el bienestar de los animales.
Es fundamental verificar que estos calefactores de piso estén encendidos durante la rutina diaria de revisión.
Debemos entender la forma en que los cerdos pierden calor para poder comprender cómo podemos evitar o manejar ciertas alzas o bajas de temperatura y ser más eficientes en este proceso. Existen 4 formas para realizar este intercambio:
Radiación
Convección
Conducción
Mecanismos de intercambio de calor 1. 3. 2. 4.
Evaporación
porciNews A. Latina Junio 2024 | Efectos del medioambiente en el bienestar del porcino bienestar 6

RADIACIÓN
Es el intercambio de calor (pérdida o aumento) a través de ondas electromagnéticas, que ocurre cuando el cerdo emite calor hacia un ambiente más frío .
Ejemplo: Cuando la temperatura ambiental es menor que la temperatura corporal del animal la pérdida se realiza por radiación
CONVECCIÓN
Es la transferencia de calor debido al movimiento de aire en la superficie de la piel o de la circulación de la sangre transportando calor de los tejidos a la superficie corporal del cerdo.
La intensidad del intercambio de calor por convección depende de:
La diferencia de temperatura entre el cerdo y el ambiente;
La velocidad relativa del aire
Densidad del corral
Entre otros factores
Es la pérdida de calor provocada por la pérdida de agua en forma de vapor. 1. 2. 3. 4.


CONDUCCIÓN
Es la transmisión de calor que ocurre cuando dos cuerpos que poseen distintas temperaturas se ponen en contacto de tal manera que el cuerpo más caliente pierde calor hacia el más frío hasta que se llega a un equilibrio
La intensidad del intercambio de calor por conducción depende de:
La diferencia en la temperatura entre superficie
El área que está en contacto
La conductividad térmica
Entre otros factores.
EVAPORACIÓN


porciNews A. Latina Junio 2024 | Efectos del medioambiente en el bienestar del porcino bienestar 7
Cuando la temperatura ambiental supera la temperatura corporal, los primeros 3 mecanismos dejan de ser eficientes en la pérdida de calor.
El enfriamiento por evaporación es el proceso predominante cuando la temperatura ambiente supera la temperatura de la piel (Robinson, 2004) y en consecuencia, en situaciones de estrés térmico aumenta la frecuencia respiratoria para acentuar la pérdida de calor por evaporación compensando la pérdida mínima que se produce por sudoración.

Esto ocurre, por ejemplo, cuando se realiza la carga de animales en un día cálido. Dentro del camión, sin estar este en movimiento, los cerdos experimentarán estrés térmico. La pérdida de calor por radiación, conducción y convección no será suficiente, por lo que los cerdos se encontrarán jadeando (evaporación), aumentando, más aún, la temperatura y humedad dentro del camión.
La intensidad del intercambio por evaporación depende de:
Temperatura ambiental
Humedad relativa
Densidad de animales
Diseño camión de transporte
Entre otros factores.
J. Y Mutua (2020) presenta una metodología innovadora para mapear el riesgo actual y futuro de estrés por calor en cerdos. Destaca que, hasta la fecha, la principal estrategia de adaptación al estrés térmico en estos animales ha sido la modificación física de su entorno, tal como evidencian investigaciones previas (Mayorga et al., 2019; Schauberger et al., 2019) Además, señala una oportunidad prometedora en la cría de cerdos con mayor tolerancia al estrés térmico, como sugerido por Bloemhof et al. en 2008.
Niu, 2023 en su paper compara los impactos del estrés térmico inducido por el cambio climático en la productividad porcina y en base en los resultados su modelo en estudio, proyectaron el impacto del estrés térmico en la producción porcina a largo plazo en sistemas con y sin avances tecnológicos.
Y destaca que al incluir en los sistemas productivos los avances tecnológicos, las pérdidas disminuirán en un 21 % y un 52 %, respectivamente, en comparación con el escenario sin avances tecnológicos.
En la revisión de 2014 realizada por Centurión, titulada “Ambiente térmico y bienestar de los cerdos en el período de descanso previo al sacrificio”, se destacan importantes hallazgos de estudios anteriores que subrayan la relación entre las condiciones térmicas y la respuesta fisiológica en los cerdos.
Uno de estos estudios, llevado a cabo por Curtis en 1983, concluyo que la temperatura cutánea es una de las primeras señales de respuesta al estrés térmico en mamíferos, incluyendo los cerdos, quienes comienzan a jadear cuando su temperatura cutánea supera los 35 °C.
Otro estudio relevante, realizado por Kiefer et al. en 2010, observó que la tasa respiratoria de los cerdos de engorde se incrementa significativamente, de 41 a 93 movimientos respiratorios por minuto, cuando la temperatura ambiental se eleva de 21 °C a 32 °C. Estos hallazgos subrayan la importancia de controlar y ajustar el ambiente térmico para asegurar el bienestar de los cerdos, especialmente en las fases críticas previas al sacrificio.
porciNews A. Latina Junio 2024 | Efectos del medioambiente en el bienestar del porcino bienestar 8
Pardo (2022) en su revisión bibliográfica halló que la ingesta de alimento puede disminuir desde un 15 % hasta un 60% y asoció como principal factor la temperatura ambiental (figura 1).
REDUCCIÓN DE LA INGESTION
Figura 1. Efecto del estrés por calor en la ingesta del ganado porcino ( Pardo, 2022)
(°C)
La reducción de la ingesta trae aparejada una disminución en la ganancia media de peso (figura 2), dando lugar a canales más magras y pequeñas, lo que supone una menor productividad y pérdidas económicas (Serviento 2020).
REDUCCIÓN DE LA TASA DE CRECIMIENTO TEMPERATURA (°C)

Ma y col., 2019
Renaudeau y col., 2001
y col., 2013a
y col., 2001
y col., 2014
y col., 2018
Collin y col., 2000
y col., 2015
Kim y col., 1992
Becker y col., 1992
Serviento y col., 2020b
Kerr y col., 2003
Teixeira y col., 2021
Figura 2. Efecto del estrés por calor en la tasa de crecimiento en ganado porcino (Pardo, 2022)
EXPERIMENTAL (DÍAS)
Ma y col., 2019
Cruzen y col., 2015
Gabler y col., 2018
Boddicker y col. 2014
Le bellego y col., 2002
Serviento y col., 2020a
TEMPERATURA
PERÍODO EXPERIMENTAL (DÍAS) REFERENCIA 59% 36 7
50% 35 30
49% 29 42
47% 35 1,3,7
30% 31 16,20 Renaudeau
30% 35 35 Boddicker
28% 32-36 3 Gabler
27% 37,4 3
25% 33 12
21,5% 32 77 Cruzen
21% 40,5 28
19% 35 28,35
19% 32 20
Fernández y col., 2013
Pearce
y col., 2018
Abuajamieh
15% 33 8
13,2% 30 15
PERÍODO
REFERENCIA 62% 35 30
28% 32 28
28% 32-36 3
26% 35 35
29 -
11% 28-34 20
16%

FACTORES FÍSICOS
Existen varias opciones pero en esta ocasión hablaremos de los sonidos e infraestructura.
Sonidos
Los animales están expuestos a sonidos continuamente a lo largo de su vida, sin embargo, puede haber ocasiones en que estos sonidos sean percibidos como algo negativo por el animal.
Un estudio realizado por Talling en 1996 concluye que un incremento en los niveles de ruido sobre los 97 decibelios (dB) provoca un aumento en la movilidad de los animales mientras están expuestos a dicho sonido. Esta observación sugiere que los niveles elevados de ruido pueden inducir estados de inquietud en los animales, lo cual es una consideración importante para el manejo y monitoreo de ambientes en los que se albergan animales.
El sonido puede ser un factor estresante en estas y otras situaciones debido a su novedad e intensidad, especialmente cuando existen otros factores estresantes, como un aumento de la temperatura.
Las condiciones de vida ruidosas y los niveles en los que una cerda reacciona a un lechón sugieren que la falta de respuesta de la cerda a los lechones se debe a las condiciones ambientales.
En muchas granjas porcinas equipadas con sistemas de ventilación mecánica, es común que se registren niveles de ruido que superan constantemente los 80 decibelios (dB), según lo documentado por Zurbrigg en 2015. Este ambiente puede tener impactos significativos en la conducta y bienestar de los animales.
Por ejemplo, Hutson y colaboradores (1993) observaron que las cerdas solo responden a las llamadas de los lechones cuando estas se reproducen a un volumen superior al habitual que fluctúa entre 84 y 86 dB.
Además, investigaciones realizadas por Agers y Jensen en 1985 sugieren que los altos niveles de ruido pueden interferir con los patrones normales de lactancia.
Estos hallazgos subrayan la necesidad de considerar y manejar adecuadamente los niveles de ruido en las instalaciones porcinas para no perturbar las interacciones entre las madres y sus crías.
Infraestructura
En el marco de una evaluación de bienestar animal, es crucial considerar los factores ambientales como indicadores indirectos. Estos deben evaluarse de manera objetiva, utilizando indicadores que no solo sean válidos, sino también viables.
Por ejemplo, la evaluación de la infraestructura del alojamiento se clasifica como un indicador indirecto. Esto implica una revisión detallada de las condiciones de esta y las condiciones físicas en las que se encuentran los animales, asegurando que estas instalaciones cumplan con los requisitos necesarios para promover un estado óptimo de bienestar animal.
porciNews A. Latina Junio 2024 | Efectos del medioambiente en el bienestar del porcino bienestar 10
2

Dentro de los componentes críticos de la infraestructura en sistemas productivos, tanto intensivos como extensivos, es fundamental destacar varios elementos clave.
Entre estos, el tipo de piso y su estado es de gran importancia, variando desde el material de cama en sistemas de deepbedding, pisos de slat, concreto, rejillas, madera, entre otros materiales disponibles para estos fines.
Asimismo, las paredes, techo, puertas y barreras protectoras, como mallas o rejillas son esenciales para prevenir el ingreso de aves o cualquier otro animal ajeno al sistema.
Las áreas comunes como pasillos, rampas, y áreas en que se realizan ciertos manejos productivos como pesaje, también deben ser evaluadas.
Una gran responsabilidad recae en los empleados de granja, quienes no solo se encargan del cuidado diario de los animales, sino que también deben realizar inspecciones obligatorias de la infraestructura cada día.
Esta revisión meticulosa es esencial para detectar a tiempo cualquier daño o deterioro. Al identificar problemas, los empleados deben informar de inmediato al encargado de mantenimiento para que se tomen las medidas correctivas necesarias
Este proceso asegura que se mantenga un ambiente seguro y funcional, previniendo así cualquier riesgo de daño para los animales.
Holendováet al. (2007) y Tummaruket al. (2008) reportó en su estudio que los problemas relacionados con la locomoción era la causa más común de desecho de cerdas en un 27% y 37.4%, respectivamente.
Las razones de desecho por problemas del aparato locomotor son más frecuentes en las cerdas jóvenes.
El tipo de alojamiento y tipo de piso utilizados se asocian con un mayor riesgo de desecho en cerdas (D‘Allaire y Drolet, 2006).
3 FACTORES SOCIALES
Los cerdos son animales sociales y jerárquicos. Establecen su jerarquía desde el primer día de vida por medio de la dominancia y la subordinación.
Desde el primer día de vida o tras la mezcla de animales desconocidos, los cerdos tendrán que establecer este orden. Se pueden observar agresiones durante este proceso que es completamente normal y es debido al comportamiento natural del animal.
La literatura indica que estos conflictos suelen consistir en vocalizaciones o movimientos de lo cabeza que pueden ir seguidos empujones en lo cabeza o en la espalda.
La mayoría de las peleas entre los cerdos se producen con el hocico abierto.
Los dientes de los cerdos pueden provocar cortes o laceraciones.
Los movimientos de empuje hacia arriba con lo cabeza se pueden generar lesiones, hematomas principalmente observados en cara, flancos o espalda.
porciNews A. Latina Junio 2024 | Efectos del medioambiente en el bienestar del porcino
11
bienestar
Cada vez que se realice mezcla de animales, ya sea por la etapa productiva que sigue o por una mala condición de cercos divisorios entre corrales o cualquier causa, ocurrirá esto.
La literatura indica que ciertos productos o elementos pueden ser utilizados con el objetivo de disminuir estos conflictos ya sea por aceites, aromas, feromonas, enriquecimiento ambiental, entre otros y evaluar los efectos benéficos o si hay o no efectos sobre el tiempo de establecimiento de la jerarquía, el estrés, número de peleas, tipo y número de lesiones y en consecuencia menos pérdida de calidad de carne.
Transporte animal
Durante el transporte, también se deben considerar factores físicos, ambientales y sociales que pueden afectar el bienestar porcino.
Los resultados de muchas investigaciones sobre el transporte de animales demuestran que a medida que aumenta el tiempo de transporte los efectos negativos incrementan sobre el bienestar de los animales y la calidad de la carne en aquellos animales de finalización.
Por lo que se debe considerar:
Hora de la carga
Tiempo de ayuno
Capacitación de cuadrilla de carga
Estrés de los animales por carga
Genética
Tiempo de carga
Condición del camión
Tipo de camión
Infraestructura interna (pisos paredes)
Densidad por corral
Tipo de animal cargado
Conducción
CONCLUSIÓN
Podemos ver que hay varios factores en el medio ambiente que puede afectar o tiene relación directa con el bienestar porcino.
Es por esto por lo que una buena práctica es comenzar a realizar auditorías internas por medio de auditores de primera parte o First Party
generalmente realizadas por un encargado de calidad o encargado de bienestar animal que realicen evaluaciones en los sitios
para poder evaluar las condiciones in situ o de tercera parte o third party
empresa externa, un agente certificador que realice auditorias de diagnóstico.
Estos ojos externos, pueden detectar aquellas desviaciones o problemas que puedan afectar, directa o indirectamente, el bienestar del animal y poder tomar las decisiones oportunas a tiempo.
Efectos del medioambiente en el bienestar del porcino
DESCÁRGALO EN PDF
ACCEDER A BIBLIOGRAFÍA
porciNews A. Latina Junio 2024 | Efectos del medioambiente en el bienestar del porcino bienestar 12
BIENESTAR PORCINO
Encontrarás consejos prácticos para mejorar el bienestar de tus cerdos_

Colaboradora

Calendario de vídeos
Enero
Febrero
M. Verónica Jiménez Grez
Médico Veterinario
MSc Etología y Bienestar Animal
Auditora de Bienestar Animal
Instructora de Bienestar Animal

Marzo
Abril
Revive el 2023
Prop 12 en Producción Porcina. ¿Cumples con los requisitos para exportar a California, EE. UU.?
Bienestar porcino y calidad de carne
Efectos del ambiente sobre el bienestar porcino
¿Cómo mover animales en granja? Consejos prácticos
Junio
Julio Mayo
Agosto
Septiembre
Octubre
Noviembre
Diciembre
Aplicación de los 5 dominios en producción porcina
Bienestar Animal y Seguridad Alimentaria
Perspectiva de los sistemas productivos porcinos latinoamericanos y sus principales retos en materia de bienestar
Aspectos económicos de las mejoras relacionadas al bienestar animal
¿Producción en confinamiento o a campo? Pros y Contras
Sitio 1: Alternativas tecnológicas de alojamientos en gestación y maternidad
Inteligencia artificial: aplicación en planta de faena para identificación de lesiones
porcinews.com/abc/abc-bienestar-porcino
¡ NUEVA S E CCIÓN!
LOS DESAFÍOS DEL STREPTOCOCCUS SUIS SEROTIPO 9 EN
LA PRÁCTICA
Carlos Eduardo Real Pereira1, Lucas Fernando dos Santos2, José Lúcio dos Santos2
1 Universidade Federal de Viçosa, UFV, Viçosa-MG
2 Microbiologia Veterinária Especial, Microvet, Viçosa-MG
Streptococcus suis (S. suis) serotipo 9 ha surgido como un desafío apremiante en la porcicultura brasileña, especialmente en el sur del país, provocando pérdidas sustanciales en la industria.
Esta cepa de S. suis se ha convertido en una amenaza significativa, causando considerables impactos económicos y sanitarios debido a su capacidad para causar enfermedades graves en cerdos, como meningitis, septicemia y artritis.


porciNews A Latina Junio 2024 | Los desafíos del Streptococcus suis serotipo 9 en la práctica 14 patología

El aumento de la prevalencia y propagación del serotipo 9 de S. suis en la región acentúa la urgencia de comprender y abordar los retos específicos que este agente etiológico plantea para la sanidad animal y la sostenibilidad de la porcicultura.
En este artículo analizaremos las actualizaciones recientes y las repercusiones que esta cepa bacteriana ha tenido en la porcicultura, destacando las pérdidas económicas y las medidas necesarias para mitigar su propagación e impacto.
De los 29 serotipos reconocidos de S. suis, el serotipo 2 es el que se aisla más frecuentemente, tanto en cerdos como en humanos, en todo el mundo.

Sin embargo, la prevalencia del serotipo 9 ha aumentado significativamente en China, varios países europeos y, más recientemente, en Brasil, donde se ha convertido en uno de los serotipos más frecuentes en cerdos.
INTRODUCCIÓN
Streptococcus suis es un coco Gram-positivo, considerado uno de los principales patógenos en cerdos a escala mundial y un agente zoonótico emergente en humanos.
La infección por S. suis afecta predominantemente a los lechones, causando meningitis, sepsis, poliserositis, artritis y endocarditis. La transmisión a los humanos se produce principalmente por contacto ocupacional o consumo de carne de cerdo mal cocida.
Las variaciones en el potencial patógeno y la estructura poblacional de las cepas del serotipo 9 como agente etiológico de enfermedades porcinas han aumentado en los últimos años en muchos países europeos.
En Brasil, el diagnóstico de meningitis causada por S. suis se registró por primera vez en 1980 y desde entonces se ha convertido en endémico en la

porciNews A Latina Junio 2024 | Los desafíos del Streptococcus suis serotipo 9 en la práctica 15
patología
Los lechones se infectan con S. suis poco después de nacer, posiblemente a través de las vías respiratorias.
La transmisión horizontal es especialmente relevante durante los brotes, cuando los cerdos enfermos liberan una gran cantidad de bacterias, lo que aumenta la propagación por contacto directo o aerosoles.
EL AUMENTO DEL SEROTIPO 9
Un estudio de 2014 mostró que los serotipos más prevalentes en el mundo aislados de animales enfermos eran los serotipos 2, 9, 3, 1/2 y 7, y alrededor del 15,5% de cepas no serotipables.
Sin embargo, en este estudio se hizo hincapié en que había un claro efecto geográfico en la distribución de los serotipos, pero esa esta cifra estaba influida por el número de estudios publicados.

Curiosamente, el serotipo 9 parece ser más prevalente en los países europeos productores de cerdos, como los Países Bajos, España, Alemania y Bélgica, por encima de otros serotipos. Los datos epidemiológicos han revelado un aumento preocupante de la prevalencia del serotipo 9 en los últimos años, especialmente en China y Brasil.

La presencia de factores predisponentes que comprometen la inmunidad del animal contribuye a la aparición de la enfermedad, que afecta principalmente a los lechones desde la segunda semana tras el destete hasta el final de la fase de cría.
porciNews A Latina Junio 2024 | Los desafíos del Streptococcus suis serotipo 9 en la práctica 16 patología
La propagación geográfica del serotipo 9 de S. suis puede verse influida por varios factores, como las prácticas de manejo de los cerdos, el transporte y las condiciones ambientales.
Los sistemas de producción porcina intensiva pueden favorecer la proliferación de S. suis 9, mientras que el transporte de cerdos vivos contribuye a su propagación a nuevas zonas.
Además, los climas más cálidos ofrecen un entorno favorable para que la bacteria sobreviva y se propague.
PROPAGACIÓN GEOGRÁFICA
Prácticas de manejo
Transporte de animales vivos
Condiciones ambientales
Climas cálidos
Sistemas de producción intensiva

En los últimos cinco años, Brasil ha registrado un preocupante aumento de casi el 20% en la frecuencia de aislamientos de S. suis serotipo 9, especialmente en la fase de recría (Figura 1).
2011 a 2018
Serotipo 9 Otros
2019 a 2024
Figura 1. Streptococcus suis serotipo 9: Prevalencia em fase de recría (transición) en comparaión con otros serotipos.
(*17/04/2024 – datos de 2024)
120% 98,2% 1,8% 21,7% 78,3% 100% 80% 60% 40% 20% 0%
porciNews A Latina Junio 2024 | Los desafíos del Streptococcus suis serotipo 9 en la práctica 17
patología

El análisis detallado de los sitios de aislamiento revela un escenario preocupante. Al examinar la frecuencia de aislamientos de S. suis 9 por zona de aislamiento, surge un patrón alarmante. En los últimos cinco años (2019 a 2024), los casos de poliartritis y meningitis han mostrado un aumento significativo (22,8% y 18,5%, respectivamente).
Cuando analizamos el origen de S. suis 9 en Brasil, observamos una similitud significativa con la cepa europea y la cepa china.
Esta similitud genética puede ayudarnos a identificar si la cepa prevalente en el sur de Brasil está presente en otras regiones del mundo y también a identificar rutas de diseminación de la bacteria entre diferentes países.
Esto podría implicar la investigación de:
el comercio internacional de animales, el movimiento de productos de origen animal y
el rol potencial de los viajeros (Figura 2).
Total 6 99 530 416 655 76 1.782
porciNews A Latina Junio 2024 | Los desafíos del Streptococcus suis serotipo 9 en la práctica 18 patología

Análisis filogenético de Streptococcus suis Serotipo 9: Relaciones entre aislamientos de granjas brasileñas (2019-
United Kingdom (CP134473)
Netherlands (NZ_LR738724)
1.000
CARACTERÍSTICAS ÚNICAS Y PATOGENICIDAD DEL SEROTIPO 9
Un estudio chino exploró la diversidad genética y la virulencia de los aislados de S. suis serotipo 9 en China. El análisis MLST reveló una elevada diversidad genética entre los aislados de S. suis 9, siendo únicos la mayoría de los tipos identificados.
Aunque S. suis 9 mostró una mayor variación genética en comparación con el serotipo 2, más comúnmente aislado, ambos compartían el linaje CC1 potencialmente virulento.
Además, las investigaciones proteómicas identificaron algunos compuestos proteínicos/ enzimáticos relacionados con la virulencia de las cepas de S. suis 9, entre ellos: DNasa, o-acetilserina, fosfoglicerato mutasa.
PR, Brazil
Brazil
China
Denmark
Germany
Netherlands
Spain
Thailand
United
Kingdom
En un estudio reciente, se evaluaron algunos supuestos genes de virulencia y se demostró que estaban presentes en cepas patógenas de S. suis 9, entre ellos:
Genes de adhesión (srtF) y
Genes reguladores de la vía metabólica (lspA, sodA, adcR, scrB, ppc, troA, nox, purD, msmK, gloA, rgg y lysM).

Sin embargo, la identificación de marcadores de virulencia fiables sigue siendo una demanda pendiente para explicar la virulencia de este serotipo. En los brotes de S. suis 9 en Brasil, las tasas de mortalidad suelen oscilar entre el 10 y el 20%, pero ha habido algunos casos en los que la mortalidad alcanzó el 35% de los animales en la fase de transición.
porciNews A Latina Junio 2024 | Los desafíos del Streptococcus suis serotipo 9 en la práctica 19
patología
TRANSMISIÓN
La transmisión de S. suis en cerdos se produce generalmente por contacto directo entre cerdos infectados y sanos, así como a través del ambiente contaminado y la transmisión vertical de la madre a los lechones.
Las medidas de bioseguridad, como una higiene adecuada, el control de vectores y la prevención del contacto entre cerdos de diferentes orígenes, son esenciales para reducir la propagación de la bacteria en las piaras de cerdos.
Un estudio realizado por Dekker en 2013 investigó el impacto de la separación de los cerdos en la tasa de transmisión del serotipo 9 de S. suis.
El estudio constató que aunque todos los cerdos, tanto los inoculados directamente con la bacteria como los que tenían contacto indirecto con ellos, estaban colonizados por S. suis 9, la tasa de colonización era significativamente menor (unas 36 veces menor) en los animales que tenían contacto indirecto.
La separación de los animales redujo notablemente la tasa de transmisión en el experimento.
Aunque cada cerdo expuesto indirectamente sólo tiene una pequeña probabilidad de infectarse, la probabilidad de que al menos uno de ellos contraiga la infección es considerable y aumenta bruscamente a medida que aumenta el número de cerdos infectados en la nave de origen.

Una vez que se ha producido la transmisión indirecta, la transmisión directa aumenta aún más la carga infecciosa y, en consecuencia,
aumenta la exposición del resto de cerdos no infectados y
la probabilidad de que se produzca una nueva transmisión indirecta, que probablemente se produzca a través de partículas de polvo contaminadas.
porciNews A Latina Junio 2024 | Los desafíos del Streptococcus suis serotipo 9 en la práctica 20 patología
Otras vías indirectas de propagación de S. suis, como a través de los operarios, se consideran menos probables debido a las estrictas medidas de bioseguridad aplicadas.
La transmisión de S. suis depende no sólo del tipo de contacto entre cerdos, sino también de la infectividad de la cepa y de la susceptibilidad de los animales, que puede verse afectada por cuestiones de manejo o incluso por cambios en el comportamiento del hospedador.


Esto podría ocurrir, por ejemplo, tras mezclar cerdos de distintos orígenes, lo que daría lugar a peleas, que modificarían la frecuencia y/o intensidad del contacto entre los cerdos.
Además, el estrés inducido por la mezcla podría aumentar aún más la susceptibilidad de los animales e incrementar la excreción de cerdos ya infectados.
ESTRATEGIAS DE CONTROL Y PREVENCIÓN
El tratamiento de los lechones infectados por S. suis suele implicar un enfoque multifacético, que puede incluir el uso de antimicrobianos, terapia de apoyo y medidas de control ambiental.

A pesar de la sensibilidad de S. suis a diversos antimicrobianos, la aparición de resistencias múltiples pone de manifiesto la importancia de realizar pruebas de sensibilidad para orientar la terapia recomendada.
porciNews A Latina Junio 2024 | Los desafíos del Streptococcus suis serotipo 9 en la práctica 21 patología
Los antibióticos más utilizados son las penicilinas, las cefalosporinas, las fluoroquinolonas y las tetraciclinas.

Concomitantemente con la terapia antimicrobiana, es aconsejable administrar agentes antiinflamatorios y analgésicos.
Teniendo en cuenta la posibilidad de anorexia y deshidratación en los animales afectados, debe llevarse a cabo una terapia de apoyo para ayudar a la recuperación.
Esto puede incluir fluidoterapia, mediante el uso de sondas o aplicadores de vacunas orales,
Es esencial reducir los factores de estrés en el entorno. En este contexto, son esenciales estrategias como la limpieza y desinfección rigurosas de las instalaciones, el control de la temperatura y una ventilación adecuada, así como el control de la densidad.

DESCARGAR BIBLIOGRAFÍA
Otro punto que debe abordarse es la inmunización del lote. Las vacunas están disponibles y pueden ser eficaces, pero una selección cuidadosa de las cepas y el desarrollo de una vacuna autógena personalizada son esenciales para garantizar una protección adecuada.
Antes de poner en marcha un programa de inmunización, es esencial aislar y serotipar las cepas presentes en la granja para formular la vacuna.
Los desafíos del Streptococcus suis serotipo 9 en la práctica
DESCÁRGALO EN PDF
porciNews A Latina Junio 2024 | Los desafíos del Streptococcus suis serotipo 9 en la práctica 22 patología

DESPÍDETE DE ELLAS



Actúa frente a todos los estadios pre-adultos de insectos y arácnidos

OHSAS 18001 www.bioplagen.com
PREVENCIÓN Y CONTROL DE LA TRANSMISIÓN DE ENFERMEDADES A
TRAVÉS DEL ALIMENTO
Pedro E. Urriola
Profesor Asociado en el Departamento de Ciencias Animales de la Universidad de Minnesota


PUNTOS A TENER EN CUENTA
La propagación de patógenos a través del alimento tiene una gran relevancia para la industria de la alimentación balanceada. En este contexto, los investigadores han centrado sus esfuerzos en demostrar la capacidad de supervivencia de virus en ingredientes, dietas completas y superficies relacionadas con la producción y distribución de alimentos balanceados.


1 ESPECIAL EVALUACIÓN DE RIESGOS porciNews A Latina Junio 2024 | Prevención y control de la transmisión de enfermedades a través del alimento 24 bioseguridad
2 3


El análisis de riesgos es una herramienta esencial que posibilita la evaluación cualitativa y cuantitativa del riesgo de propagación de una enfermedad en situaciones predefinidas.
En el ámbito de la seguridad alimentaria, es esencial llevar a cabo una evaluación y gestión de los riesgos para asegurar la inocuidad de los alimentos que consumimos.

Hemos desarrollado un modelo cuantitativo de evaluación de riesgos para utilizarse como base para estimar el riesgo de la entrada de la PPA a los EE.UU. y otros países libres de la enfermedad a través de otros tipos de importaciones de ingredientes de alimento susceptibles de contaminación.
Podría aplicarse en el desarrollo de estrategias para mitigar riesgos y establecer puntos críticos de control con el propósito de inactivar el virus de la PPA durante los procesos de elaboración, almacenamiento y transporte de ingredientes alimentarios.
4

Un enfoque equilibrado y basado en análisis de riesgo proporciona un marco sólido para gestionar de manera eficiente la seguridad alimentaria y la salud de los animales, garantizando así resultados positivos tanto en términos de prevención de enfermedades como de optimización de la producción.

Porcina Africana (PPA o ASF por sus siglas en inglés) es uno de los principales retos a nivel mundial para los veterinarios.
En los países donde esta enfermedad es endémica, ha causado innumerables pérdidas a los productores de cerdos y ha empeorado la seguridad alimentaria.

porciNews A Latina Junio 2024 | Prevención y control de la transmisión de enfermedades a través del alimento 25 bioseguridad
Aunque existen diversas vías de transmisión de enfermedades infecciosas como la PPA, la ruta de transmisión a través del alimento es crucial para la industria de alimentos balanceados (Shurson et al., 2022).
En este sentido, los investigadores han centrado su atención en demostrar la supervivencia del virus de la PPA en ingredientes, dietas completas y superficies involucradas en la producción y distribución de alimentos balanceados (Dee et al., 2018).
Aunque estos experimentos demuestran la supervivencia del virus en condiciones de laboratorio simuladas, aún no existe evidencia que respalde la transmisión actual del virus a través del alimento ni una cuantificación de la frecuencia con la que ocurre dicha transmisión.
Por lo tanto, el propósito de este manuscrito es describir los esfuerzos recientes para cuantificar el riesgo de transmisión de la PPA en ingredientes destinados a las dietas de cerdos, ya sean importados o producidos en los EE.UU.
Conceptos clave para comprender el análisis de riesgo
El análisis de riesgo es una herramienta fundamental que permite evaluar de manera semicuantitativa y cuantitativa el riesgo de transmisión de una enfermedad en escenarios predeterminados (WHO, 2002).

En este sentido, el término “peligro” (en inglés “Hazard”) se refiere a la capacidad de una acción o evento de causar daño.
Por su parte, el “riesgo” se define como la probabilidad de que ocurra un evento perjudicial.

Es fundamental destacar esto, ya que gran parte de la literatura sobre la supervivencia de virus, como el de la PPA en el alimento, no llega a cuantificar la probabilidad de que se produzca el evento en cuestión.
porciNews A Latina Junio 2024 | Prevención y control de la transmisión de enfermedades a través del alimento 26 bioseguridad
El siguiente ejemplo ilustra la diferencia entre riesgo y peligro en el contexto de la seguridad alimentaria:

Análisis de riesgo de la supervivencia de la PPA en soya importada
Se ha confirmado que el virus de la PPA puede sobrevivir cuando se introduce experimentalmente en ciertos ingredientes de piensos bajo condiciones ambientales que simulan el transporte transoceánico (Schambow et al., 2022).
Probabilidad de enfermedad por consumir carne cruda contaminada. Si decides cocinar la carne a una temperatura segura antes de comerla, el riesgo de enfermarse por las bacterias presentes en la carne disminuye significativamente. PELIGRO
Bacterias patógenas en carne cruda. Imagina que tienes carne cruda en tu cocina que contiene bacterias dañinas como la Salmonella. Estas bacterias tienen la capacidad de causar enfermedades si se consumen.

En seguridad alimentaria es crucial evaluar y gestionar tanto los peligros como los riesgos para garantizar la seguridad de Los alimentos que consumimos.
No obstante, estos modelos no abordaron la probabilidad de supervivencia del virus en distintos intervalos de tiempo y a diversas temperaturas a las que los ingredientes de los alimentos se ven expuestos antes de incorporarse a las dietas porcinas.
En este contexto, hemos desarrollado un modelo cuantitativo de evaluación de riesgos con el fin de estimar la probabilidad de que uno o más buques oceánicos que transporten harina de maíz o soya (25,000 toneladas) contaminados con la PPA sean importados anualmente a los EE. UU., utilizando la siguiente ecuación:

pPPA = [p0 × (1 − p1) + (p0 × p1 × pR) + (1 − p0) × pR] × (1 − p2) × (1 − p3)
RIESGO
porciNews A Latina Junio 2024 | Prevención y control de la transmisión de enfermedades a través del alimento 27 bioseguridad
¿Dónde?:
pPPA es la probabilidad de importación del Virus de PPA en uno o más buques oceánicos.
p0 es la probabilidad de contaminación inicial por el virus de la PPA.
p1 es la probabilidad de inactivación del virus durante el procesamiento.
pR es la probabilidad de re-contaminación del alimento ya procesado.
p2 es la probabilidad de inactivación del virus durante el transporte.
p3 es la probabilidad de inactivación del virus durante la espera en el despacho aduanero.
Para modelar p1, empleamos datos relacionados con maíz y las condiciones de procesamiento de la soya (ya sea mediante extrusión o extracción con disolventes), incluyendo los tiempos y las temperaturas.
Utilizamos también valores D (tiempo necesario para reducir en un 90% o 1-log) derivados de estudios de inactivación térmica de la PPA en suero de cerdo y supervivencia en ingredientes de alimento durante el transporte transoceánico.
Exploramos diversos escenarios hipotéticos mediante la utilización de valores deterministas para p0 y pR (1%, 10%, 25%, 50%, 75% y 100%) con el objetivo de evaluar su influencia en el riesgo.
Nuestro modelo estimó la inactivación completa de la PPA después de la extrusión o extracción con disolventes, independientemente de la probabilidad inicial de contaminación con el virus.
Se evidenció que el valor de la re-contaminación (oscilante entre el 1% y el 75%) tuvo un impacto significativo en el riesgo de que un contenedor de harina de soya contaminada con el virus de la PPA ingresara a EE. UU.
Las estimaciones medianas de riesgo variaron desde un 0.064% [0.006%–0.60%; intervalo de probabilidad del 95%], asumiendo un valor de p0 del 1,0%, hasta un 4.67% (0.45%–36.50% intervalo de probabilidad del 95%), suponiendo un valor de pR del 75.0%.

En otras palabras, esto implica que se importaría al menos un contenedor con harina de soya contaminada con el virus de la PPA una vez cada 1563 a 21 años, respectivamente.

porciNews A Latina Junio 2024 | Prevención y control de la transmisión de enfermedades a través del alimento 28 bioseguridad
Si consideramos el supuesto de que todo el maíz crudo estaba contaminado (p0 = 100%) y no hubiera re-contaminación (pR = 0%),
la mediana de probabilidad de que un buque con maíz contaminado con PPA ingresara a EE.UU. sería del 2.02% (0.28%–9.43% intervalo de probabilidad del 95%) o una vez cada 50 años
Los valores de re-contaminación entre el 1% y el 75% no alteraron de manera significativa el riesgo asociado al maíz.
Resultó evidente que los días de transporte, la supervivencia del virus durante el mismo (valor D) y el número de buques embarcados fueron los parámetros más influyentes para aumentar la probabilidad de que un contenedor de harina de soya o maíz contaminado con el virus de la PPA ingresara a los EE.UU.

El modelo contribuyó a identificar las lagunas en el conocimiento que ejercen un mayor impacto en los valores de producción y desempeñó un papel como un marco de referencia que podría ser actualizado y ajustado a medida que se dispusiera de nueva información científica.
En última instancia, este modelo podría aplicarse en el desarrollo de estrategias para mitigar riesgos y establecer puntos críticos de control con el propósito de inactivar el virus de la PPA durante los procesos de elaboración, almacenamiento y transporte de ingredientes alimentarios.

Asimismo, contribuiría al diseño y a la aplicación de medidas de bioseguridad orientadas a prevenir la introducción del virus de la PPA en los EE.UU. y en otros países libres de la enfermedad.
porciNews A Latina Junio 2024 | Prevención y control de la transmisión de enfermedades a través del alimento 29 bioseguridad
Análisis de riesgo cuantitativo de la supervivencia de la PPA en plasma
porcino
En la alimentación animal y en los ingredientes de los alimentos, no existen límites reglamentarios microbiológicos específicos para los virus (Sampedro et al., unpublished).
Con este contexto en mente, se propuso en este estudio el concepto de objetivo de rendimiento (PO) para la producción de lotes de plasma porcino secado por atomización (SDPP), con la meta de lograr la ausencia de partículas virales infecciosas.

La concentración media del virus de la Peste Porcina Africana (VPPA) en plasma porcino crudo se estimó en 0.6 log HAD50/ml (0.1-1.4, IC 95%) en un escenario previo al brote, que involucraba la recolección de plasma de cerdos virémicos asintomáticos y no detectados.
Se estimaron niveles de PO de -7.0, -7.2 y -7.3 log TCID50/g para tres tamaños de lote (10, 15 y 20 toneladas) de SDPP.
Mediante una encuesta exhaustiva sobre la presencia del virus de la diarrea epidémica porcina (PEDV) en plasma porcino crudo producido globalmente, se reveló una concentración de -1.0±0.6 log TCID50/ml, calculada a partir de una curva estándar derivada de TCID50 -qPCR.
Para cumplir con los niveles de PO propuestos en este estudio, se evaluaron distintos escenarios de procesamiento, incluyendo el enfoque de línea base:
Secado por atomización + almacenamiento con calor, así como el enfoque línea base + radiación ultravioleta (UV).
Los resultados demostraron que tanto la línea de base como la línea de base + los escenarios de procesamiento UV superaron el umbral del 95% y el 100% respectivamente, logrando así el cumplimiento con los niveles de PO requeridos para el PEDV, y todo esto adaptado a diferentes tamaños de lote.


porciNews A Latina Junio 2024 | Prevención y control de la transmisión de enfermedades a través del alimento 30 bioseguridad
En relación con la PPA en el SDPP antes del brote, se logró una tasa de cumplimiento del 100% en todos los escenarios de procesamiento evaluados.
Sin embargo, es imperativo llevar a cabo investigaciones adicionales para discernir los mecanismos subyacentes de la inactivación viral en los alimentos durante el almacenamiento.
Esta comprensión más profunda es esencial para impulsar la implementación de esfuerzos efectivos en la gestión de riesgos de seguridad alimentaria a nivel global.
CONCLUSIÓN
Los análisis de riesgo representan una herramienta esencial para la toma de decisiones informadas.
Sin su aplicación, se corre el riesgo de adoptar enfoques ineficaces que dejan puertas abiertas a la propagación de enfermedades.

Por otro lado, es importante destacar que intervenciones innecesarias pueden incrementar los costos de producción y restringir el uso de productos alimenticios y aditivos que han demostrado ser beneficiosos en las dietas de cerdos.

En última instancia, un enfoque equilibrado y basado en análisis de riesgo proporciona un marco sólido para gestionar de manera eficiente la seguridad alimentaria y la salud de los animales, garantizando así resultados positivos tanto en términos de prevención de enfermedades como

DESCÁRGALO EN PDF Prevención y control de la transmisión de enfermedades a través del alimento DESCARGAR BIBLIOGRAFÍA porciNews A Latina Junio 2024 | Prevención y control de la transmisión de enfermedades a través del alimento 31 bioseguridad
EVALUACIÓN DEL RIESGO DE INTRODUCCIÓN DE UN PATÓGENO A
UNA GRANJA Y SU
IMPACTO ECONÓMICO
Laura Batista, Batista & Asociados Asesora para el sector porcino mundial, México/Canadá
Es bien conocido que, en los últimos años, los brotes con diferentes patógenos, especialmente los virales, como, por ejemplo, el virus de la de la Fiebre Porcina Africana, del Síndrome
Reproductivo y Respiratorio del Cerdo (PRRS), y de la Influenza Porcina (IP) han causado la muerte de millones de cerdos en muchos países del mundo.
Por lo tanto, una comprensión adecuada de la dinámica de transmisión y de los factores de riesgo para la propagación epidémica de estos virus es la clave para diseñar estrategias de prevención y control eficaces.



ESPECIAL EVALUACIÓN DE RIESGOS porciNews A Latina Junio 2024 | Evaluación del riesgo de introducción de un patógeno a una granja y su impacto económico 32 bioseguridad
Que aunado a un análisis del impacto productivo y económico de la enfermedad, nos permitirá implementar estas estrategias y controles sin que las consideremos un gasto si no una inversión que siempre nos ofrecen un rápido retorno a la inversión.
Antes de entrar en detalle con el análisis de riesgo en una granja porcina, los invito a que revisen está página, presionen: “your disease risk”, y que respondan el cuestionario, el resultado, les dará un ejemplo muy claro de lo que es un análisis de riesgo y su aplicación, en este caso, en su persona.
RESPONDER CUESTIONARIO
Definamos, el riesgo es el resultado de la multiplicación de la probabilidad de que se produzca un evento y sus consecuencias negativas.
En nuestra granja, esto sería la probabilidad de que un patógeno sea introducido, entre en contacto con los cerdos y cause una enfermedad con su consecuente impacto productivo y económico.
Por ejemplo, un camión contaminado con un patógeno infeccioso sería el peligro, la probabilidad de que

RIESGO
Brote infeccioso

PELIGRO
Camión contaminado
PROBABILIDAD
Que entre en contacto con los cerdos

Gráfico 1. Ecuación del cálculo del riesgo
El resultado de un análisis de riesgo, una herramienta epidemiológica, es la información que se obtiene al medir e interpretar los diferentes indicadores de riesgo, y nos permite, entre otros:
Prevenir la introducción de uno o varios patógenos, y por lo tanto evitar su impacto productivo y económico.

Predecir la introducción de un patógeno a nuestro sistema de producción.
Lograr un diagnóstico correcto.
Establecer las relaciones causales.
Planear y ejecutar un plan sanitario de control efectivo.
porciNews A Latina Junio 2024 | Evaluación del riesgo de introducción de un patógeno a una granja y su impacto económico 33 bioseguridad
Por lo tanto, el uso del análisis de riesgo(s) es muy útil, y debe ser continuo, ya que la producción porcina es un proceso dinámico donde constantemente cambian los factores mencionados en el Gráfico 1
Actualmente, contamos con sistemas muy eficientes de monitoreo de bioseguridad y trazabilidad en tiempo real, mismos que facilitan mucho este análisis.


Identi cación del riesgo
Acceso al riesgo
Proceso de manejo del riesgo
Revisión de los controles
Control del riesgo
Gráfico 2. Manejo básico del riesgo. Adaptado de Polson, D. 2023
El alimento del personal Mascotas y roedores
Alimentación
BAJO RIESGO
Agua potable
Aire
Material y equipo
Este análisis nos permite tomar decisiones objetivas, por ejemplo, en los programas de bioseguridad, capacitación de personal, manejo y/o de salud ya implementados en la granja, y sus futuros ajustes. (Gráfico 2).
Los invito a que hagamos un análisis de riesgo para identificar la interacción de todas las variables y factores de riesgo que pueden influir, en su granja, para la introducción, establecimiento y diseminación de un patógeno
Este análisis de riesgo debe basarse en lineamientos técnicos y científicos, y no en creencias y/o paradigmas para lograr un proceso de decisión documentado y efectivo (Gráfico 3).
Vehículos de transporte, personas, ropa, calzado, etc.
Cerdos contaminados (pie de cría, semen, animales para engordar)
ALTO RIESGO
Gráfico 3. Importancia relativa de las diferentes vías de transmisión de patógenos entre granjas. Modificado de Dewulf, J. 2020
porciNews A Latina Junio 2024 | Evaluación del riesgo de introducción de un patógeno a una granja y su impacto económico 34 bioseguridad

El análisis de riesgo se divide en cuatro fases, en este caso utilizaré como ejemplo, el riesgo de contaminación por un vehículo:

Identificación del peligro = Camión contaminado
14/02/2024 11:01:35 14/02/2024 18:02:21
15/02/2024 08:36:54
14/02/2024 12:33:10 14/02/2024 19:40:05 15/02/2024 11:10:18 15/02/2024 12:17:02 15/02/2024 15:06:19 15/02/2024 16:54:31
Gráfico 4. Adaptado de Soriano, O. y Batista, L. (ADA 2024)
2

15/02/2024 07:47:26
3
Evaluación del riesgo:
Evaluación de la introducción (difusión) = Que el camión contaminado entre al área gris o limpia de la granja sin ser lavado, secado y desinfectado. Recuerden que NO hay ningún desinfectante que sea efectivo en presencia de material orgánico, por lo que el lavado con detergente, desengrasante, y de preferencia con agua caliente, son el paso MÁS importante de este proceso.
A B C D
Evaluación de la exposición = Que el material contaminado del camión entre en contacto con los cerdos de la granja.
Evaluación de las consecuencias = Enfermedad.
Estimación del riesgo = Impacto productivo y económico que dependerá del sistema de producción de cada granja (v.g. flujo continuo, producción en bandas, sitios o multisitios).



2021
Gestión del riesgo = Aplicar las medidas efectivas control
4
Comunicación del riesgo = A nuestro equipo, a nuestros vecinos, y en caso de ser necesario a las autoridades.
PASO 1
PASO 2
PASO 3
1
?! ?!
porciNews A Latina Junio 2024 | Evaluación del riesgo de introducción de un patógeno a una granja y su impacto económico 35 bioseguridad
Geghardt, J.
Antes de iniciar un análisis de riesgo y obtener respuestas adecuadas, debemos tomar en cuenta la interacción y evaluación de la triada epidemiológica, que incluye las interacciones entre los diferentes elementos que intervienen para que se produzca una enfermedad (Gráfico 5), la historia natural de la enfermedad, y la cadena epidemiológica del patógeno.
Recordemos que no es posible extrapolar la dinámica de infección de un virus, con el de una bacteria o un parásito.
Ahora bien, existen dos tipos de análisis de riesgo:
1- CUANTITATIVO
2- CUALITATIVO
1
Medioambiente
AGENTE INFECCIOSO
Huésped

Agente etiológico
5. Las relaciones de la triada epidemiológica
Probabilidad
Cuantitativo, que nos proporcionan una estimación matemática sobre las probabilidades y la magnitud de las consecuencias sanitarias, productivas y económicas que podrían ocurrir. (Gráfico 6).
MANEJO DE RIESGO Impacto


Gráfico 6. Matriz de riesgo de la posibilidad de la introducción de un patógeno a una granja porcina. Adaptado de Riveras A., 2017.

 Gráfico
Gráfico
Muy Bajo 0,05 Bajo 0,1 Medio 0,2 Alto 0,4 Altamente Probable 90% 0,05 0,09 0,18 0,36 Probable 70% 0,04 0,07 0,14 0,28 Poco Probable 50% 0,03 0,05 0,10 0,20 Eventual 30% 0,02 0,03 0,06 0,12 Raro 10% 0,01 0,01 0,02 0,04
INSTALACIONES, POBLACIÓN YOTROS. CERDOS
porciNews A Latina Junio 2024 | Evaluación del riesgo de introducción de un patógeno a una granja y su impacto económico 36 bioseguridad

2 Cualitativo, que implicaría un enfoque descriptivo como se puede observar en el Gráfico 7.
Presencia de aves silvestres migratorias y/o endémicas infectadas
Granjas predios afectados
Educación y capacitación de trabajdores
Sistema de desinfección de vehículos Cerco perimetral
Prevalencia regional
Mallas pajareras
Uso de módulos sanitarios
Control de ingreso de trabajadores visitantes e insumos
Fallas en el programa de cigilancia epidemiológica
Fallas en la disposición de cadáveres y desechos
Probabilidad de la introducción de un patógeno infeccioso a un sitio de producción de porcino
Falla en la aclimatación del reemplazo
Falla en la implementación de un programa de vacunación y medicación efectivo
Fallas en el control de la fauna nociva
Uso inadecuado de desinfectantes y sanitizantes
Fallas en el control de plagas en bodegas y silos de alimentos
Fallas de en manejo y tratamiento de excremento
Fallas en el lavado, limpieza y desinfección de instalaciones y equipo

porciNews A Latina Junio 2024 | Evaluación del riesgo de introducción de un patógeno a una granja y su impacto económico 37 bioseguridad
Actualmente, dos parámetros muy objetivo de nuestra eficiencia productiva, y que es muy sencillo de calcular, son los kilogramos destetados y vendidos/ hembra/año, y la conversión alimenticia global granja.
Estos dependerán de los días no productivos de las hembras, el tamaño de camada, peso al destete y a la venta, y salud de los cerdos en todas las etapas de producción, que sabemos, impactarán en el porcentaje de mortalidad, de retrasados y la desviación de peso de cada lote.
Para calcular estos tres parámetros solo requerimos: los kilogramos destetados totales, vendidos y el total del alimento comprado en el año.
Soy más eficiente produciendo:
12 destetados de 6.5 kg = 78 kg x 2.3 partos/hembra/año = 179.4 kg / hembra año, que
14 destetados de 5.5kg = 77 kg x 2.3 partos/hembra/año = 177.1 kg / hembra/año
Sabiendo que:
AUna hembra no debe comer más de 1,000 a 1,200 kg/año, sobre todo si nos apoyamos en las nuevas tecnologías de alimentación de precisión, para producir los kilogramos de lechón mencionados anteriormente.

Imagen 2. Sistema de alimentación de precisión.

BLas camadas muy numerosas implican manejo extra, ya que existe una mayor variabilidad en el peso de los lechones al nacimiento, que complica la ingesta adecuada de calostro, y al destete por competencia por leche durante toda la lactancia.
Es bien sabido que los lechones de bajo peso son más susceptibles a enfermarse durante toda su vida y tienen menor ganancia de peso diaria (GDP), y por ende una mayor conversión alimenticia (CA).
porciNews A Latina Junio 2024 | Evaluación del riesgo de introducción de un patógeno a una granja y su impacto económico 38 bioseguridad








CUn lechón de 6.5 kg es más robusto, y por lo tanto, se adapta mejor a su nuevo medio ambiente y requiere de un alimento con menor cantidad de proteína, logrando así un objetivo realista de:

30-32 kg a los 70 das de edad
130 kg a los 160 dias
Conversión alimenticia global granja
(CAG) de 2.5.

D

Una ganancia diaria de peso menor implica una mayor permanencia en granja, aumentano los costos y limita una mayor rotación de los edificios, que incluye un menor tiempo de lavado, secado y desinfección que impactará de manera negativa en la efectividad del programa sanitario de la granja
En conclusión, una vez que tenemos determinados los riesgos de la introducción o diseminación de una enfermedad en nuestra granja, usemos el sentido común, y hagamos inversiones preventivas, que siempre serán mucho más efectivas que los costos adicionales en los que se incurren para corregir el impacto productivo y económico de una o varias enfermedades.
No esperen a que llegue “el lobo” y derrumbe nuestra producción, la moral de nuestro equipo y afecte negativamente nuestro retorno a la inversión.
Evaluación del riesgo de introducción de un patógeno en mí granja y su impacto económico
DESCÁRGALO EN PDF
Imagen 3. (Fuente: Remus, A. 2020)
35 30 25 20 15 10 05 00 01 02 03 04 porciNews A Latina Junio 2024 | Evaluación del riesgo de introducción de un patógeno a una granja y su impacto económico 39 bioseguridad
ESTRATEGIAS DE MANEJO DURANTE LA GESTACIÓN
Y LACTANCIA EN GENÉTICAS MODERNAS
Artículo traducido y adaptado de “Bortolozzo, F.P.; Zanin, G.P.; Ulguim, R.d.R.; Mellagi, A.P.G. Managing Reproduction in Hyperprolific Sow Herds. Animals 2023, 13, 1842. https://doi.org/10.3390/ani13111842”
Comprender los mecanismos fisiológicos responsables del desarrollo reproductivo y productivo de los genotipos de cerdas modernos ayudará a crear o adaptar recomendaciones de manejo para la granja.
En el artículo anterior se abordaron los principales desafíos y prácticas de manejo asociados a la selección de reposición y la gestación. En esta edición avanzaremos sobre el parto, la lactancia y el intervalo destete estro.
ACCEDE AL ARTÍCULO ANTERIOR



porciNews A Latina Junio 2024 | Estrategias de manejo durante la gestación y lactancia en genéticas modernas 40 manejo
Con camadas más numerosas,
La duración del parto aumenta de ese sale:
aumentando la cantidad de nacidos muertos comprometiendo la salud puerperal de la cerda
La cantidad de calostro disponible por lechón es menor
El número de lechones nacidos vivos supera el número de tetas funcionales.
De esta manera, las camadas numerosas trajeron enormes desafíos. El catabolismo lactacional es intenso en cerdas con más lechones lactantes.
Sumado a esto, los lechones pueden experimentar más competencia por el acceso al pezón durante el período de lactancia.
Características del parto en cerdas hiperprolíficas y sus consecuencias
Uno de los parámetros utilizados a nivel mundial es la cantidad de lechones destetados, y si bien ha sido mejorado con los avances genéticos, las tasas mortalidad de lechones antes del destete siguen siendo altas (Figura 1)
Esta elevada mortalidad puede estar asociada con eventos durante el parto, como partos prolongados, distocia e hipoxia.
Figura 1. Tendencias brasileñas en número total de lechones nacidos, porcentaje de momias, nacidos muertos y mortalidad antes del destete. Datos de 2021 recopilados de 1715 granjas y 1.538.548 cerdas


10.0 9.0 8.0 7.0 6.0 5.0 4.0 3.0 2.0 1.0 0.0 Porcentaje de lechones Lechones nacidos totales Años 2008 2009 2010 2011 2012 2013 2014 Nacidos muertos Momias Nacidos totales Mortalidad pre destete 2015 2016 2017 2018 2019 2020 2021 15.0 14.5 14.0 13.5 13.0 12.5 12.0 10.0 5.0 0.0
porciNews A Latina Junio 2024 | Estrategias de manejo durante la gestación y lactancia en genéticas modernas 41
manejo
La duración de los partos ha ido aumentando con los años, presumiblemente debido al aumento del tamaño de la camada. Por ejemplo, en 2005, la duración media del parto era de 166 min, y en la actualidad ha aumentado a 268 min.
Varios factores, además del tamaño de camada, pueden afectar la duración del parto, como:
una elevada condición corporal el estreñimiento el sistema de alojamiento el número de mortinatos el uso de oxitocina la genética
Las consecuencias de los partos prolongados y la distocia son, en la mayoría de los casos, negativas para la cerda:
El ambiente uterino está expuesto a la contaminación y los agentes patógenos ingresan fácilmente a su interior cuando se realizan manipulaciones obstétricas.
Es común la hipertermia en los primeros 3 días posparto, así como una disminución del apetito y del consumo de agua, comprometiendo la salud general de las cerdas y predisponiéndolas a una reducción en la producción de leche y posterior desempeño.
Pérdidas neonatales: incidencia de mortinatos y lechones de baja viabilidad
Los partos prolongados están fuertemente correlacionados con el tamaño de la camada y los mortinatos.
Oliviero et al. informaron que un parto de duración prolongada (>300 min) resultó en un promedio de 1,5 lechones nacidos muertos por camada, mientras que un parto de duración normal (<300 min) resultó en 0,4 lechones nacidos muertos.
Las consecuencias del sufrimiento fetal, ya sea causado por partos prolongados o distocia, implican una menor viabilidad de los lechones después del nacimiento.
Los últimos lechones nacidos son más propensos a la muerte fetal, con informes de tasas de muerte fetal del 3,6%, 10,1% y 21,7% en lechones del orden 1 al 9, 10 al 13 y 14, respectivamente.



porciNews A Latina Junio 2024 | Estrategias de manejo durante la gestación y lactancia en genéticas modernas 42 manejo
Los lechones que tardan más en nacer tienden a tener el cordón umbilical roto al momento del parto y, en consecuencia, sus posibilidades de muerte al tercer día pueden aumentar 3 veces en comparación con los lechones con el cordón intacto.
Por lo tanto, está claro que los factores que influyen en la muerte fetal también influyen en la aparición de lechones de baja viabilidad
Las camadas de cerdas hiperprolíficas tienen una ingesta reducida de calostro a nivel individual.
A la diminución en la ingesta individual de calostro en camadas numerosas se suma la presencia de lechones de bajo peso al nacer y el aumento de competencia por los pezones.
Además, los lechones con baja vitalidad pueden retrasar el consumo de calostro, aumentando el riesgo de muerte.
Por lo tanto, es fundamental que se adapten algunas prácticas en la supervisión del parto y en los protocolos de manejo de los lechones el día del parto.
En lo que respecta a la cerda, el parto es físicamente exigente y las cerdas se vuelven propensas al: agotamiento
insuficiencia cardíaca lesiones físicas reducción de la inmunidad
Los partos prolongados pueden aumentar el porcentaje de hembras con hipertermia (≥39,0 °C) en las primeras 24 h posparto y reducir su apetito.
Una de las condiciones clínicas observadas con frecuencia es el síndrome de disgalactia posparto (PPDS), caracterizado por una producción insuficiente de calostro y leche en los primeros días posparto.
Las hembras con una duración del parto ≥300 min tenían 1,5 veces más probabilidades de tener intervalos desteteestro prolongados en 1 día en comparación con las cerdas que tuvieron un intervalo entre partos <300 min .



porciNews A Latina Junio 2024 | Estrategias de manejo durante la gestación y lactancia en genéticas modernas 43 manejo
Estrategias y herramientas para optimizar el rendimiento en el parto
Reducir la duración del parto implica varios enfoques. Aunque los uterotónicos (p. ej., oxitocina o sus análogos) pueden reducir la duración del parto, la administración en el proceso temprano aumenta la tasa de muerte fetal.
Está establecido que los uterotónicos deben administrarse si no hay obstrucción, en presencia de contracciones débiles y después de otras medidas de asistencia obstétrica.
La intervención obstétrica manual es otra práctica para ayudar cuando se aumenta el intervalo entre nacimientos de los lechones, con el objetivo de aumentar la supervivencia de los lechones y reducir la duración del parto. Este procedimiento se observa con mayor frecuencia en cerdas de mayor edad y durante el verano, probablemente debido al menor tono muscular y al agotamiento físico.
En muchas granjas, las cerdas se alimentan una vez al día hasta el parto, lo que resulta en un período prolongado de baja disponibilidad de energía. Como el parto es un evento que exige energía para la cerda, expulsar una camada de gran tamaño es un desafío.
Además, se espera estreñimiento unos días antes del parto debido al bajo consumo de alimento por parte de la hembra, lo que puede provocar partos prolongados.
La restricción de la alimentación antes del parto provoca hipoglucemia y menos energía disponible para la intensa contracción que requerirán el útero y los músculos abdominales.
La alimentación adecuada de las cerdas en la fase de transición desde el final de la gestación hasta el comienzo de la lactancia es esencial para asegurar un crecimiento fetal y mamario adecuado, el parto y la producción de calostro.
Aumentar el consumo de fibra de las cerdas antes del parto puede aliviar el grado de estreñimiento.

Feyera et al. demostró una correlación negativa entre los niveles de glucosa en sangre y la duración del parto.
En ese estudio, el intervalo desde la última comida hasta el inicio del parto afectó la duración del parto, lo que sugiere que las cerdas en gestación tardía deberían recibir al menos tres comidas diarias para evitar concentraciones bajas de glucosa en el parto.
Los glucocorticoides pueden aumentar la producción de glucosa al estimular la proteólisis, la lipólisis y la gluconeogénesis hepática.
Por otro lado, controlar el peso y la condición corporal de las cerdas es esencial para obtener un mejor rendimiento, una mayor longevidad del plantel y un uso óptimo del alimento.
porciNews A Latina Junio 2024 | Estrategias de manejo durante la gestación y lactancia en genéticas modernas 44 manejo

Las hembras con grasa dorsal alta (>17 mm) han mostrado partos 155 minutos más largos en comparación con el espesor de grasa dorsal baja. Se cree que en este fenómeno están implicados el descenso retardado de la progesterona en el periparto y el aumento de grasa alrededor del canal del parto.
Es importante tener en cuenta que las cerdas con sobrepeso pueden tener una producción reducida de calostro y una ingesta de alimento limitada durante la lactancia, lo que compromete la producción de leche.
Manejo de cerdas lactantes y destetadas
La producción de leche para camadas grandes requiere una importante movilización de reservas corporales, ya que se prioriza la ingesta de nutrientes para la producción de calostro y leche.
Sin embargo, la ingesta de alimento suele ser insuficiente para satisfacer todas las necesidades nutricionales y las cerdas movilizan reservas corporales, lo que resulta en un estado catabólico.
En las últimas dos décadas, ha habido evidencia de que los genotipos modernos son más resistentes y retornan al estro después del destete, pero los efectos negativos sobre la tasa de concepción y el tamaño de la camada posterior persisten.
El desarrollo del folículo puede verse comprometido en un estado de catabolismo, perjudicando la tasa de ovulación y la supervivencia del embrión.
Los genotipos modernos manifiestan estro en un promedio de 4,8 días después del destete y tienen una tasa de anestro más baja.
Una semana después del destete, se espera que entre el 90% y el 95% de las cerdas multíparas presenten estro. Por tanto, para las cerdas es difícil recuperar las reservas corporales antes del servicio.
Las estrategias para reducir la pérdida excesiva de peso incluyen:
manejo nutricional de las primerizas y de las hembras gestantes, control de las temperaturas en las unidades de maternidad, acceso ad libitum a alimento y agua y atención médica para las cerdas lactantes.
En los últimos años, la industria porcina se ha centrado en aumentar la edad de destete. Aunque se reportan muchas ventajas para los lechones, como se analiza más adelante, el aumento de la duración de la lactación puede estar asociado con diferentes estrategias de manejo para las cerdas.
Un período de lactancia más prolongado facilita una mejor involución uterina antes de la inseminación.
Por cada día que aumentó el intervalo parto-destete, las cerdas produjeron:
0,19 lechones más por año
0,32 lechones más hasta el cuarto parto
porciNews A Latina Junio 2024 | Estrategias de manejo durante la gestación y lactancia en genéticas modernas 45
manejo
Manejo del lechón
El número de pezones funcionales en la hembra moderna es, en promedio, 13,9, y el número de lechones nacidos vivos es superior a 15 por lo tanto, se requieren protocolos de manejo que permitan equilibrar camadas con número de pezones funcionales.
Adopciones
La crianza cruzada es una estrategia utilizada para reducir la variación de peso dentro de la camada y para mantener una cantidad de lechones que puedan consumir calostro y leche de manera adecuada, eliminando el excedente de lechones del número de tetas funcionales.
Suele realizarse durante los 2 primeros días de vida antes de establecer el orden de los pezones y asegurar el consumo de calostro.
Sin embargo, se debe tener cuidado en cómo se realiza el movimiento de los lechones.
Sousa et al. observaron que los lechones livianos no deben ser cruzados con lechones pesados para evitar perder episodios de lactancia y comprometer la tasa de supervivencia. De manera similar, Vande Pol et al. destacó la recomendación de crianza cruzada de lechones livianos en camadas con peso uniforme. Sin embargo, no se observaron diferencias cuando se cruzaron lechones livianos con lechones de peso intermedio.
Socialización de la camada antes del destete
Una alternativa para mejorar el rendimiento pre y post-destete es la socialización de la camada. Un estudio en el que se eliminó la barrera entre dos corrales adyacentes, permitiendo a los lechones interactuar antes del destete, mostró una reducción en el comportamiento agresivo y la aparición de lesiones.
Además, se informó una mejor tasa de crecimiento en la fase posterior al destete.
En los sistemas tradicionales de maternidad, las fallas en el desempeño de los lechones son comunes debido a peleas por los pezones o la baja producción de leche por parte de una glándula mamaria, lo que puede perjudicar su crecimiento.
Al permitir el acceso a más de una cerda, los lechones tienen la oportunidad de acceder a otras tetas (lactancia cruzada) que de otro modo podrían estar disponibles y no utilizarse.
Sin embargo, en un estudio previo también se encontró una mayor puntuación de lesiones en los pezones en cerdas, junto con lesiones en la piel en lechones de camadas socializadas (realizadas el día 14 de lactación). Curiosamente, los cerdos socializados tuvieron un 19% menos de lesiones cutáneas que el grupo de control después del destete.
Independientemente del momento de socialización (7 o 14 días de vida), los lechones mostraron conductas más agresivas y de juego que los lechones control; sin embargo, el número de lesiones cutáneas indicó que los lechones mezclados peleaban menos.




porciNews A Latina Junio 2024 | Estrategias de manejo durante la gestación y lactancia en genéticas modernas 46 manejo
Cerdas nodrizas y alimentación suplementaria
En muchos planteles hiperprolíficos, las cerdas nodrizas pueden representar entre el 10 y el 15% de las hembras lactantes, y algunos muestran una prevalencia de hasta el 50%.
Actualmente se utilizan dos estrategias:
En la estrategia de un solo paso, una cerda recién destetada cría lechones recién nacidos sobrantes.
En la estrategia de dos pasos, la cerda destetada cría una camada a partir de una cerda intermedia después de 5 a 10 días de lactancia. La cerda intermedia se traslada para acoger a los lechones sobrantes recién nacidos.
En ambas estrategias, se prolonga la duración de la lactación, con el objetivo de aumentar la supervivencia pre-destete de los lechones en un grupo de parto determinado. Aunque es una práctica común entre las granjas, existe una gran variación en la metodología, lo que dificulta el establecimiento de un protocolo estándar.
Además, es posible que algunas cerdas no acepten la camada adoptiva o que experimenten una producción de leche reducida debido a la latencia hasta la primera lactancia.
Los lechones de acogida presentan más disputas por los pezones, falta de lactancia y menores tasas de crecimiento.
La lactancia prolongada puede provocar lesiones en los pezones mala condición corporal al destete problemas locomotores diseminación de agentes patógenos
Según Garrido-Mantilla et al., esta estrategia de manejo puede facilitar la transmisión de los virus de la influenza A y PRRS entre cerdas lactantes y lechones.





porciNews A Latina Junio 2024 | Estrategias de manejo durante la gestación y lactancia en genéticas modernas 47
manejo
Destete precoz
La suplementación nutricional puede ser una alternativa para aumentar la vitalidad del lechón y su capacidad para ingerir calostro/leche, ayudando a compensar las bajas reservas corporales.
El destete precoz implica mantener a los lechones en recintos especializados equipados con lámparas, comederos y bebederos sustitutos de agua, leche y alimento sólido.
Este sistema puede sustituir a las cerdas nodrizas o puede utilizarse para criar lechones enfermos y de baja. Como los lechones tienen libre acceso al sustituto de la leche, el peso al destete es mayor, pero el bienestar y el rendimiento post-destete ocasionalmente se ven influenciados negativamente.
Edad de destete
El destete representa una transición abrupta del alimento líquido al sólido y la formación de una nueva jerarquía social (alojamientos con lechones “desconocidos”).
A pesar del suministro de dietas altamente digeribles después del destete, esta práctica se asocia con una reducción abrupta en el consumo de alimento en los primeros días, combinado con el estrés jerárquico generado en las nuevas instalaciones.
El destete tardío puede beneficiar el desarrollo de la barrera intestinal y reducir los parámetros inmunológicos relacionados con el estrés.
Este manejo ofrece resultados interesantes en camadas numerosas, minimizando la mortalidad de los lechones, mejorando el peso al destete y disminuyendo la variación dentro de la camada.
Las principales limitaciones de la suplementación a los lechones, como fuente nutricional única o complementaria, son la elevada inversión y mantenimiento de estos sistemas, además de los problemas relacionados con el bienestar animal cuando los lechones se ven privados del contacto materno.


El aumento de la edad de destete de 19 a 28 días afectó positivamente el rendimiento de los cerdos en la lactancia y aumentó el peso por cerdo destetado, lo que indica 25 días como la edad óptima.
Además, el aumento de la edad de destete de 18,5 a 24,5 días afectó positivamente el rendimiento de los cerdos al reducir el número de cerdos tratados, aumentar la ganancia diaria promedio y el consumo de alimento y reducir marginalmente las pérdidas totales de los cerdos.
Por lo tanto, aumentar la edad de destete es particularmente importante en sistemas donde el uso de antibióticos está más restringido.
porciNews A Latina Junio 2024 | Estrategias de manejo durante la gestación y lactancia en genéticas modernas 48 manejo

CONCLUSIONES
Las piaras hiperprolíficas son un desafío para la producción porcina, ya que las hembras presentan requisitos distintos y los lechones pueden tener dificultades para desarrollarse y sobrevivir.
Además de esto, la creciente preocupación por el bienestar animal, como la gestación en alojamiento grupal y el aumento de la edad de destete, requiere más esfuerzos para garantizar que una mayor prolificidad se traduzca en una mejor cantidad y calidad de los lechones destetados, además de mejorar la longevidad de las cerdas.
En consecuencia, el manejo de granjas hiperprolíficas incluye
cerdas de reemplazo bien manejadas,
mejor manejo durante la gestación, atención a partos prolongados, prácticas destinadas a aumentar el consumo de calostro y leche, y estrategias para criar lechones que excedan el número de tetas funcionales disponibles en la sala de partos.

Es evidente, por lo tanto, que se debe mejorar el manejo general de los cerdos para satisfacer las demandas de las cerdas, los lechones y la industria.
Aunque destacamos el importante manejo de las cerdas y la camada para maximizar la producción porcina, la magnitud de cada factor que influye puede diferir entre las granjas.
Por lo tanto, es primordial que cada sistema identifique todos los aspectos previamente discutidos para implementar la gestión recomendada.
Estrategias de manejo durante la gestación y lactancia en genéticas modernas
DESCÁRGALO EN PDF
porciNews A Latina Junio 2024 | Estrategias de manejo durante la gestación y lactancia en genéticas modernas 49 manejo
DESCARGAR BIBLIOGRAFIA

PLACENTACIÓN: ANÁLISIS DEL IMPACTO EN EL PESO FETAL – PARTE II
Leticia P. Moreira, Saffir D. Fernandes, João Vitor L. Ferreira, Abner Shinkawa, Dayanne K. O. Pires, Isadora M. S. de Oliveira, Stephanny R. Rainha, Túlio C. C. de Alkmim, José Andrés Nivia Riveros, Fernanda R. C. L. Almeida Instituto de Ciências Biológicas da Universidade Federal de Minas Gerais
La primera parte del artículo “Análisis del impacto en el peso fetal – Parte 1” hacía hincapié en la estructura de la placenta en el cerdo.
ACCEDE AL ARTÍCULO
En esta segunda parte del artículo, veremos los factores que contribuyen a la ineficiencia placentaria.
Tamaño de la camada
Existen pruebas de que el peso medio de los lechones al nacer disminuye a medida que aumenta el tamaño de la camada.
Sin embargo, no se han encontrado estudios que muestren una relación clara entre el tamaño de la camada y la vascularización placentaria.
Las características de la placenta y la incidencia de la mortalidad predestete parecen estar asociadas con el peso del lechón al nacer.
Tanto la superficie placentaria (-20,4%) como el peso de la placenta (-14,8%) fueron inferiores en los lechones que murieron antes del destete en comparación con los supervivientes de la misma especie.
Reproducción 50 porciNews A.Latina Abril 2024 | Placentación: Análisis del impacto en el peso fetal - Parte II

Así, en camadas más grandes, el flujo sanguíneo placentario por lechón se reduce y el área placentaria por lechón es menor, lo que explicaría por qué el peso medio al nacimiento de los lechones es menor, así como el aumento de la incidencia de mortalidad antes del destete.
Una mejor comprensión de las complejas interacciones entre el flujo sanguíneo placentario y otras características de la cerda moderna puede aportar información sobre la reducción de pérdidas perinatales.
Insuficiencia placentaria: posibles causas y consecuencias
En la porcinocultura moderna hay varios factores que afectan al crecimiento del feto y el desarrollo fetal y placentario durante la gestación:
Calidad de los ovocitos
Duración del celo
Implantación
Factores genéticos
Factores epigenéticos
Factores ambientales
Nutrición de la cerda
Capacidad uterina
A continuación, exploraremos algunos de los factores relevantes que contribuyen a una placentación ineficiente en cerdos.
Genética
En los cerdos, el factor genético interfiere directamente en el desarrollo placentario.
Las placentas de las hembras Yorkshire aumentan de tamaño y superficie durante el último tercio de la gestación, a diferencia de las placentas Meishan, en las que el crecimiento se mantiene constante durante el final de la gestación, pero con un drástico aumento de la densidad de vasos sanguíneos en la interfase placenta/ endometrio que permiten una mayor irrigación.

Por lo tanto, existen diferencias genéticas y de desarrollo placentario entre las distintas líneas genéticas, de modo que la placenta de Yorkshire muestra una mayor eficiencia por área de placenta en comparación con Meishan.
Reproducción 51 porciNews A.Latina Abril 2024 | Placentación: Análisis del impacto en el peso fetal - Parte II
Capacidad uterina
Diversos estudios revelan que la capacidad uterina puede afectar el crecimiento pre natal.
Según Alvarenga-Dias e Almeida (2021), en el ambiente intrauterino, ocurre una gran competencia nutricional entre los embriones, volviéndose crítica a partir del día 30 de gestación.
Como consecuencia de la capacidad uterina, se observa asociación inversa entre el número de fetos y el crecimiento fetal, de modo que, cuanto mayor es el número de fetos dentro del útero, menos es el desarrollo fetal individual, y mayor la competencia por la irrigación placentaria.
La capacidad uterina es responsable de la variación del peso fetal de una camada, pudiendo verse afectada a medida que avanza la gestación; aumentando la proporción de fetos con menor tamaño y con mayor indice de mortalidad.
Condición corporal
Una vez que finaliza el período de lactancia, se espera que las cerdas retornen al celo en los 5 días posteriores al destete, iniciando un nuevo ciclo reproductivo.

Sin embargo, debido al marcado balance energético negativo que se produce durante la lactación, el desarrollo folicular y embrionario en las hembras en esta etapa puede verse afectado negativamente, generando una condición conocida como síndrome del segundo parto.
Como consecuencia de ese síndrome, el proceso de fertilización, implantación y desarrollo placentario se ven comprometidos. Este se debe a desbalances metabólicos que, en última instancia, pueden producir la muerte de los embriones.
Nutrición

El factor nutricional está vinculado a la condición corporal y es de suma importancia durante todas las etapas productivas de la porcinocultura, y esencialmente, durante la gestación, donde el desarrollo embrionario y fetal es ampliamente influenciado por la nutrición materna, responsable de la modulación del metabolismo placentario.
Reproducción 52 porciNews A.Latina Abril 2024 | Placentación: Análisis del impacto en el peso fetal - Parte II

Por lo tanto, dietas con restricción de nutrientes provoca estrés y, en consecuencia, afecta el desempeño productivo de las hembras. El tamaño de los fetos también puede provocar disfunción gastrointestinal al comprimir el tracto digestivo.
Esa compresión resulta en estrés oxidativo sistémico, a partir de la liberación de altas cantidades de radicales libres, que comprometen la estructura y la función intestinal.
Célula saludable Célula atacada por radicales libres
Estrés oxidativo (destrucción celular)
Por lo tanto, el estrés oxidativo puede ser un factor de complicaciones como la restricción del crecimiento intrauterino (RCIU).
Mecanismos compensatorios de una mala placentación
La supervivencia embrionaria y la capacidad uterina son los principales factores responsables de la mortalidad prenatal y del RCIU.
La capacidad uterina se refiere al número de fetos en desarrollo que son mantenidos por el útero hasta el parto.
La capacidad uterina puede afectar el crecimiento fetal a partir de los 30 días de gestación, cuando la competencia entre los lechones por el limitado espacio uterino y los nutrientes se hace más crítica.
El flujo sanguíneo uterino por feto es insuficiente a medida que aumenta el tamaño de la camada.
La eficiencia placentaria, que viene dada por el peso corporal de un lechón, dividido por la masa de su placenta. Varía sustancialmente entre los fetos de una misma camada, lo que indica que esta métrica es una característica individual.
Una de las principales causas del desarrollo fetal comprometido es el transporte insuficiente de nutrientes a través de la placenta. Los estudios indican correlaciones positivas significativas entre el flujo sanguíneo placentario, el peso placentario y el peso fetal en cerdos.
Reproducción 53 porciNews A.Latina Abril 2024 | Placentación: Análisis del impacto en el peso fetal - Parte II

La placenta de las hembras Yorkshire aumenta constantemente de tamaño y superficie durante el final de la gestación, estableciendo un entorno competitivo entre sus fetos por los nutrientes; sin embargo, las hembras Meishan aumentan notablemente la densidad de sus vasos sanguíneos en esta fase de la gestación, lo que permite que el tamaño de la placenta se mantenga constante sin comprometer el crecimiento fetal.
En un estudio realizado por Reis (2021) se observó una mayor vascularización a los 45 días de gestación en los fetos hembras de alto peso en comparación con los machos. El fortalecimiento de la vascularización tiende a aumentar el intercambio materno-fetal, permitiendo que los fetos crezcan más eficientemente en una capacidad uterina limitada y, en última instancia, proporcionando una mejor uniformidad dentro de la camada.
Así pues, garantizar un flujo sanguíneo adecuado dentro de la placenta es un mecanismo importante, junto con la superficie ocupada por el órgano para el desarrollo placentario y fetal. Las tasas de flujo sanguíneo placentario pueden incrementarse mediante la vascularización y la vasodilatación, que están controladas por el factor de crecimiento endotelial vascular (VEGF) y óxido nítrico, respectivamente.
La eficacia de la placenta está directamente relacionada con su estructura. La longitud de los pliegues microscópicos de la capa epitelial del trofoblasto placentario/ endometrio aumenta en la placenta asociada a fetos pequeños.
Estos cambios morfométricos aumentan la superficie de interacción entre los suministros de sangre materna y fetal, mejorando así la eficacia de la placenta en respuesta al tamaño reducido de esta; sin embargo, la longitud de la región estromal era menor en placentas de fetos pequeños en comparación con los fetos grandes.
Teniendo en cuenta que el tejido estromal está formado por fibroblastos, cuyo principal producto son los glicosaminoglicanos sintetizados a partir de la glucosa, el crecimiento restringido de los fetos porcinos puede ser un reflejo de un transporte insuficiente de glucosa.

La placentación asociada a fetos con RCIU muestran una expresión alterada de proteínas relacionadas con estrés oxidativo, apoptosis, metabolismo celular y transporte de nutrientes.
Reproducción 54 porciNews A.Latina Abril 2024 | Placentación: Análisis del impacto en el peso fetal - Parte II
Consideraciones finales
En las hembras Yorkshire, se describe un aumento del tamaño de la placenta proporcional al aumento del peso de los fetos en el último tercio de la gestación, mientras que las hembras Meishan mantienen su placenta pequeña, pero extremadamente bien vascularizada, y no muestran un aumento significativo del peso de los fetos en el mismo periodo.
Un factor estrechamente relacionado con la eficiencia placentaria es el estado nutricional, ya que en el último tercio de la gestación se requiere un mayor aporte nutricional para ayudar al crecimiento fetal acelerado sin perder la viabilidad de estos animales.
Ya se ha descrito en la literatura que hembras seleccionadas para una mayor eficiencia placentaria son capaces parir aproximadamente 3,3 lechones adicionales por parto.
Placentación: Análisis del impacto en el peso fetal – Parte II DESCARGAR PDF
Referencias bajo petición.
La estructura de la placenta experimenta una serie de cambios en su estructura para permitir el crecimiento adecuado de la camada. Sin embargo, varios factores pueden poner en peligro el desarrollo de la placenta, comprometiendo su función, siendo la insuficiencia placentaria un problema importante en la producción porcina.
Placentas ineficientes provocan el nacimiento de lechones pequeños con baja viabilidad y peor desempeño. Por lo tanto, dilucidar los factores que afectan a la formación, el desarrollo y la actividad de la placenta sería el primer paso para diseñar intervenciones productivas eficaces que mejoren el rendimiento reproductivo de las cerdas en las granjas porcinas.

Reproducción 55 porciNews A.Latina Abril 2024 | Placentación: Análisis del impacto en el peso fetal - Parte II
EL USO DE GRASAS OXIDADAS EN LA ALIMENTACIÓN
PORCINA: EL HATO REPRODUCTOR
PARTE II
Gerardo Ordaz Ochoa, María Alejandra Pérez Alvarado, Luis Humberto López Hernández
Centro Nacional de Investigación Disciplinaria en Fisiología y Mejoramiento Animal, INIFAP, México
La alimentación adecuada tanto de las cerdas que integran el hato reproductor como de los verracos es fundamental para garantizar la salud y el rendimiento reproductivo en la producción porcina. Sin embargo, el creciente uso de grasas oxidadas en la dieta del hato reproductor con el supuesto objetivo de reducir costos en la alimentación genera incertidumbre por sus repercusiones en la salud y la reproducción.
GRASAS OXIDADAS Y ESTRÉS OXIDATIVO EN LA SALUD REPRODUCTIVA DE LAS CERDAS
En el procesamiento y almacenamiento de los alimentos, especialmente aquellos ricos en lípidos, se puede inducir reacciones de oxidación en las grasas (Factores que ya fueron abordados en ediciones anteriores de porciNews Latam). Estudios han demostrado que el consumo de grasas oxidadas puede tener efectos adversos en la salud reproductiva de los animales.
Por ejemplo, la oxidación de lípidos puede provocar estrés oxidativo en los tejidos, lo que se asocia con daño celular y disfunción reproductiva (Yang et al., 2023).
LEER ARTÍCULO


porciNews A Latina Junio 2024 | El uso de grasas oxidadas en la alimentación porcina: el hato reproductor. Parte 2 56 nutrición
El estrés oxidativo en los tejidos de cerdas reproductoras, asociado al consumo de grasas oxidadas, se debe a la producción excesiva de especies reactivas de oxígeno (ROS, por sus siglas en inglés) y a la disminución de los niveles de antioxidantes endógenos (Figura 1; Su et al., 2017).
Los lípidos oxidados en la dieta pueden aumentar los niveles de peroxidación lipídica en los tejidos de las cerdas, lo que conduce a la acumulación de productos de oxidación y daño en las membranas celulares (Luo et al., 2018), repercutiendo directamente en:

1 2 3 4
Reducir la calidad de los óvulos
Reducir la tasa de concepción
Aumentar la incidencia de abortos
Trastornos del ciclo estral

Figura 1. Niveles de Vitaminas E y C, glutatión peroxidasa (GPx) y superóxido dismutasa (SOD) total en cerdas reproductoras de acuerdo con el tipo de aceite y adición de antioxidantes. Modificado de Su et al., 2017.
8.0 6.0 4.0 2.0 0.0 4.0 3.0 2.0 1.0 0.0
E, mg/100ml Vitamina C, mg/100ml
Aceite no oxidado Aceite no oxidado + antioxidante Aceite oxidado Aceite oxidado + antioxidante 1.2 6.5 6.1 6.8 6.6 1.2 1.2 1.1 1400.0 1200.0 1000.0 800.0 600.0 400.0 200.0 0.0 80.0 70.0 60.0 50.0 40.0 30.0 20.0 10.0 GPx nmol/mil/mL Total SOD, U/mL GPx Total SOD Aceite no oxidado Aceite no oxidado + antioxidante Aceite oxidado Aceite oxidado + antioxidante 67.1 62.4 1291.0 1239.6 1287.5 1278.1 63.5 66.8
Vitamina
Vitamina E en suero Vitamina C en suero
porciNews A Latina Marzo 2024 | El uso de grasas oxidadas en la alimentación porcina: el hato reproductor. Parte 2 57
nutrición
Además, el estrés oxidativo puede afectar la función endocrina de las cerdas, alterando la producción y liberación de hormonas reproductivas.
La exposición a grasas oxidadas puede alterar la expresión génica relacionada con la síntesis hormonal y función metabólica en las cerdas, lo que puede comprometer más su salud reproductiva (Valle et al., 2009).
Estos hallazgos resaltan la importancia de evitar el uso de grasas oxidadas en la alimentación de cerdas reproductoras para preservar su salud reproductiva.
IMPACTO DE LAS GRASAS OXIDADAS EN LA FERTILIDAD DE LAS CERDAS
En el proceso de oxidación de las grasas se producen compuestos tóxicos, como aldehídos y peróxidos, que pueden interferir con varios procesos fisiológicos, incluida la reproducción. Para tal caso, existe una asociación entre el consumo de grasas oxidadas y una disminución en la tasa de concepción en cerdas (Zeng et al., 2023):

Las cerdas alimentadas con dietas ricas en grasas oxidadas tienen una tasa de concepción significativamente menor en comparación con aquellas alimentadas con dietas elaboradas con grasas de buena calidad (no oxidadas).
Varios mecanismos pueden explicar cómo los compuestos tóxicos generados por la oxidación de las grasas afectan la fertilidad de las cerdas, entre ellos se destacan:
1
Afectación negativa de la homeostasis hormonal de los animales, alterando la producción y la liberación de hormonas clave involucradas en la reproducción, por ejemplo, estradiol y progesterona.
2
Reducción del consumo de alimento en lactancia demeritando la condición corporal de la hembra, ello a su vez propicia baja viabilidad de los óvulos y, por lo tanto, menor fertilidad en el siguiente ciclo reproductivo (Figura 2).
3
Respuestas inflamatorias en el organismo, lo que a su vez puede afectar la salud del tracto reproductivo y la viabilidad de los óvulos y espermatozoides.
porciNews A Latina Junio 2024 | El uso de grasas oxidadas en la alimentación porcina: el hato reproductor. Parte 2 58 nutrición
Consumo de alimento/día en lactancia, kg pérdida de grasa dorsal en lactancia, mm
Consumo de alimento Pérdida de grasa dorsal

Porcentaje de los componentes nutricionales de la leche
Peso del lechón, kg
Peso del lechón al nacimiento
no oxidado + antioxidante
Peso del lechón al destete
Figura 2. Desempeño productivo de la cerda y el lechón durante la lactancia y calidad de la leche de las cerdas de acuerdo con el tipo de aceite y adición de antioxidantes. Modificado de Su et al., 2017.
5.0 4.0 3.0 2.0 1.0 0.0 5.0 4.0 3.0 2.0 1.0 0.0
Aceite no oxidado Aceite no oxidado + antioxidante Aceite oxidado Aceite oxidado + antioxidante 4.9 2.3 4.9 2.7 4.7 3 3.3 4.5 10.0 8.0 6.0 4.0 2.0
0.0
Proteína Aceite no oxidado Aceite no oxidado + antioxidante Aceite oxidado Aceite oxidado + antioxidante 5.3 6.3 8.1 5.1 5.8 8.1 5.3 5.9 8.2 5.2 5.8 8.0
6.0 5.0
Grasa Lactosa
4.0 3.0 2.0 1.0 0.0
Aceite no oxidado Aceite oxidado Aceite oxidado + antioxidante 1.5 5.7 1.5 5.7 1.5 5.6 1.4 5.4
Aceite
porciNews A Latina Marzo 2024 | El uso de grasas oxidadas en la alimentación porcina: el hato reproductor. Parte 2 59
nutrición

IMPACTO DE LAS GRASAS OXIDADAS
SOBRE LA CALIDAD DE LA DESCENDENCIA
La calidad de la descendencia es crucial para el éxito de la producción porcina, y la alimentación materna juega un papel fundamental en su desarrollo.

El consumo de grasas oxidadas por parte de las cerdas reproductoras tiene repercusiones en la calidad de la descendencia, tanto en términos de viabilidad como de rendimiento productivo.
Se ha reportado (Xu et al., 2021) que la exposición prenatal a grasas oxidadas puede afectar el desarrollo fetal y la viabilidad neonatal en cerdos, por:
El aumento en la incidencia de malformaciones congénitas y disminución en el peso al nacer en las camadas de cerdas expuestas a dietas con grasas oxidadas (Gao al., 2023).
Alterar la expresión génica y la función metabólica en la descendencia, lo que puede tener efectos a largo plazo en su salud y rendimiento productivo (Zeng et al., 2023).
porciNews A Latina Junio 2024 | El uso de grasas oxidadas en la alimentación porcina: el hato reproductor. Parte 2 60 nutrición
Dichas afectaciones de la calidad de la descendencia de cerdas que consumieron dietas ricas en grasas oxidadas se pueden asociar en parte a:
GRASAS OXIDADAS EN LA SALUD REPRODUCTIVA DE VERRACOS
El consumo de grasas oxidadas puede tener varios efectos adversos en la salud reproductiva de los verracos, afectando la calidad del semen y la función testicular (Zeng et al., 2023).

Los compuestos tóxicos que pueden tener efectos negativos en el desarrollo fetal, interfiriendo con la formación de órganos y sistemas importantes.
Aumentar la susceptibilidad de los lechones a enfermedades y trastornos metabólicos en la etapa postnatal.
Reducción de la motilidad espermática

Disminución de la concentración espermática

Mayor incidencia de anomalías espermáticas
porciNews A Latina Marzo 2024 | El uso de grasas oxidadas en la alimentación porcina: el hato reproductor. Parte 2 61
nutrición
Los mecanismos detrás del efecto negativo del consumo de grasas oxidadas en verracos aún no se comprenden completamente, pero se han reportados sus efectos debido a:
El estrés oxidativo en el organismo afecta la salud celular y la función de los órganos reproductivos.

Afectación de la síntesis hormonal y la función testicular, lo que resulta en una reducción en la producción y la calidad del semen.
IMPLICACIONES PARA LA INDUSTRIA PORCINA
El estrés oxidativo inducido por el consumo de grasas oxidadas en la dieta de las reproductoras y los verracos induce una menor eficiencia reproductiva y productiva para la industria porcina.
Por lo que, se destaca la necesidad de una mayor atención a:
La calidad de la grasa implementada en las dietas.
Almacenamiento adecuado de la materia prima.
La oxidación de las grasas puede afectar la síntesis de lípidos esenciales para la integridad de las membranas celulares, lo que afecta la función espermática.
Adecuada formulación de los alimentos para reproductores.

porciNews A Latina Junio 2024 | El uso de grasas oxidadas en la alimentación porcina: el hato reproductor. Parte 2 62 nutrición
Es crucial implementar la suplementación de antioxidantes más allá de reducir la oxidación en el alimento, sino en aminorar reacciones oxidativas en el animal producidas por otros factores estresantes.
Por lo que, se requieren más investigaciones que aumenten la comprensión de los mecanismos detrás de los efectos adversos de las grasas oxidadas sobre indicadores reproductivos de las cerdas y verracos, así como el desarrollar estrategias efectivas para mitigar estos efectos.
CONCLUSIONES
El uso de grasas oxidadas en la alimentación de cerdas reproductoras y verracos puede tener importantes repercusiones en la salud y comportamiento reproductivo, así como en la calidad de la descendencia en la producción porcina.
Los efectos adversos incluyen la disminución de la tasa de concepción, mayor incidencia de abortos y trastornos reproductivos, así como el impacto negativo en la viabilidad y el rendimiento de la descendencia.


DESCARGAR BIBLIOGRAFÍA
Por lo tanto, es crucial adoptar prácticas alimentarias que minimicen la exposición de los reproductores a grasas oxidadas, garantizando así la salud y el éxito reproductivo.

El uso de grasas oxidadas en la alimentación porcina: el hato reproductor. Parte 2
DESCÁRGALO EN PDF
porciNews A Latina Marzo 2024 | El uso de grasas oxidadas en la alimentación porcina: el hato reproductor. Parte 2 63 nutrición

EFECTOS BENÉFICOS DE UN PROBIÓTICO EN LECHONES
Constanza Stoppani Ing agrónoma (MSc)

porciNews A Latina Junio 2024 | Efectos benéficos de un probiótico en lechones 64 nutrición

Simultáneamente los animales atraviesan un estrés nutricional ya que pasan de consumir leche materna casi exclusivamente, a una dieta generalmente sólida y seca con una composición muy diferente.
En consecuencia, los primeros días posdestete suele observarse una disminución del consumo.

Se estima que al final de la primera semana posdestete la energía metabolizable consumida representa entre el 60-70% del consumo predestete y puede llevar hasta 2
Esto último puede verse acentuado por una perturbación de la microbiota del tracto gastrointestinal (TGI), conduciendo frecuentemente a la proliferación de bacterias enterotoxigénicas, principalmente Escherichia coli [2; 4].
La combinación de todos estos efectos puede producir pérdidas de peso, disminución en la tasa de crecimiento, e inclusive ocasionar la muerte de los animales [4; 6].
La creciente restricción en el uso de antibióticos promotores de crecimiento (APC) con el fin de atenuar los efectos negativos del estrés posdestete, ha llevado a la búsqueda de alternativas.
aproximadamente 24 horas posdestete se producen marcados cambios en la estructura y la función del intestino delgado, generando efectos perjudiciales [4; 5].
Cuando las funciones de dicha barrera se alteran aumenta la permeabilidad de las membranas a toxinas, bacterias y antígenos asociados a los alimentos que pueden atravesar el epitelio dando inflamación, mala
Es sabido que los probióticos, definidos como microorganismos vivos que suministrados en cantidades adecuadas confieren beneficios en la salud del huésped [7], tienen la capacidad de modular la microbiota intestinal.
Mediante mecanismos que incluyen la producción de sustancias inhibitorias como bacteriocinas, etanol, diacetil, dióxido de carbono, peróxido de hidrógeno y ácidos orgánicos podrían reducir poblaciones de microorganismos patógenos presentes en el intestino.
porciNews A Latina Junio 2024 | Efectos benéficos de un probiótico en lechones 65
nutrición
A su vez, podrían mejorar el proceso digestivo, ya sea incrementando la utilización metabólica de los nutrientes, produciendo enzimas digestivas o simplemente produciendo ácidos grasos volátiles y vitaminas del complejo B, lo que tiene efectos directos sobre la conversión alimenticia (CA).

MATERIALES Y MÉTODOS
En un estudio realizado en la Unidad Demostrativa Porcina de la EEA INTA Pergamino (Buenos Aires, Argentina) se puso a prueba el efecto probiótico sobre lechones en el posdetete de la cepa bacteriana Lactobacillus salivarius DSPV014C (actualmente denominada Ligilactobacillus salivarius).
Se trabajó con 20 lechones de genética comercial, de 28 días de vida promedio.
Los animales se alojaron de a pares, en jaulas (0,82 m2) con piso de slat plástico, comederos tipo tolva y chupetes de altura regulable.
El ambiente se mantuvo con una temperatura de 24± 3º C.
Para realizar la prueba se siguió un diseño en bloques completos aleatorizados, según peso inicial.
Dentro de cada bloque, los lechones fueron asignados al azar a dos grupos:
control (GC) probiótico
quedando constituido cada uno por 10 animales.
Las dietas de ambos grupos estuvieron compuestas por: maíz
harina de soja premezcla comercial en un programa de 3 fases alimenticias (todas libres de APC).
Dicho programa se determinó según recomendaciones comerciales, suministrándose por animal:
4 kg de fase 2
13 kg de fase 3
fase 4 desde el fin de fase 3 hasta los 70 días de vida
Cada cerdo correspondiente al GP recibió oralmente una dosis diaria ≥9,81 log de unidad formadora de colonias (UFC) de la cepa probiótica, resistente a rifampicina para posibilitar su monitoreo.
Tanto al inicio del estudio, semana 0, como en las semanas 3 y 6, se tomaron muestras de materia fecal (MF), a partir de las cuales se hicieron recuentos en placas correspondientes a
L. salivarius
Escherichia coli
Bacterias ácido láctica (BAL) totales levaduras
Campylobacter spp
porciNews A Latina Junio 2024 | Efectos benéficos de un probiótico en lechones 66 nutrición


Suministro de la cepa probiótica a los lechones del GP
Además, sobre las mismas muestras se realizó un análisis por electroforesis en gel con gradiente desnaturalizante para evaluar la dinámica poblacional de la microbiota predominante en los cerdos a través de los índices de diversidad, homogeneidad y riqueza.
A fin de evaluar el desempeño productivo se registró el peso individual al inicio (PVi) y al final del experimento (PVf); y se midió el consumo de alimento por jaula, determinándolo como la diferencia entre el alimento entregado y el sobrante.
A partir de estos datos se calculó la conversión alimenticia global.
Figura 1. Índice de diversidad, homogeneidad y riqueza del microbioma presente en la materia fecal de lechones en recría suplementados con L. salivarius DSPV014c (GP) vs sin suplementación (GC)
RESULTADOS Y DISCUSIÓN
El hecho de que L. salivarius DSPV014C resistente a rifampicina haya sido encontrado en el GP en todos los muestreos (en concentraciones superiores a 2,9 log (UFC/g MF)) indica su capacidad de resistir al medio ácido estomacal y a la bilis, alcanzando su sitio de acción.
Este resultado no fue suficiente para evidenciar diferencias en los recuentos semanales de las demás poblaciones evaluadas. Sin embargo, al caracterizar el ecosistema microbiano presente en la MF si pudo observarse una modulación de la microbiota diferente entre grupos (Figura 1).
El GP presentó valores mayores para los índices de diversidad y riqueza en la semana 3. Coincidiendo con autores que indican que a pesar de la disminución posdestete de la diversidad microbiana en el TGI, esta aumenta luego, mostrando incrementos hasta la adultez de los cerdos [8].
2,5 2 1,5 1 0,5 0 Diversidad de Shannon 0 3 6 GC GP GC GP GC GP Homogeneidad de Pielou Riqueza de Margalef
porciNews A Latina Junio 2024 | Efectos benéficos de un probiótico en lechones 67 nutrición
La mayor diversidad encontrada en el GP podría representar una ventaja respecto al GC, dado que una alta diversidad bacteriana sería favorable para la salud en general y la productividad de los animales al permitir mantener la resiliencia, resistencia y estabilidad del microbioma luego de una situación estresante.
Además, un mayor valor en dicho índice podría considerarse como signo de una microbiota con mayor madurez [8].
Según los resultados obtenidos en esta investigación, puede decirse que los cerdos del GP alcanzaron un PVf similar al GC consumiendo menos alimento, por lo que se obtuvo una mejora en la CA (Figura 2). Esto podría explicarse por la producción de ácido láctico y enzimas proteolíticas por parte de las BAL suministradas como probiótico.

La mayor concentración de ácidos orgánicos en TGI daría como resultado un menor pH, lo que puede asociarse a una mejora en la digestión de nutrientes [9; 10; 11; 12].
Además, un aumento en la cantidad de Lactobacillus podría incrementar la actividad de ciertas enzimas, como la β-galactosidasa, que tienen un efecto positivo en la utilización de los nutrientes por parte del huésped [13].

de L. salivarius

Figura 2. Indicadores productivos de lechones en recría, suplementados con L. salivarius DSPV014c (GP) vs sin suplementación (GC)
Recuento
GP 45 35 25 15 5 -5 Peso inicial Peso nal Consumo total GC GP porciNews A Latina Junio 2024 | Efectos benéficos de un probiótico en lechones 68 nutrición
En cuanto a la diferencia encontrada para la CA, podría verse aumentada en condiciones productivas (Figura 3), ya que algunos autores enuncian que los compuestos que promueven el crecimiento se vuelven más efectivos a medida que se exacerban los desafíos ambientales y nutricionales que enfrenta el animal [14; 15].
En este caso los cerdos permanecieron en óptimas condiciones sanitarias durante todo el experimento.

Figura 3. Conversión alimenticia de lechones en recría suplementados con L. salivarius DSPV014c (GP) vs sin suplementación (GC)
CONCLUSIÓN
Podría decirse que la suplementación con L. salivarius DSPV014C produjo una mejora en el desempeño productivo de los cerdos del GP al disminuir la CA. Esto se explicaría tanto por la producción de ácido láctico y enzimas proteolíticas, como por una modulación diferencial de la microbiota intestinal por parte de la cepa.

 DESCÁRGALO EN PDF
Efectos benéficos de un probiótico en lechones
DESCARGAR BIBLIOGRAFÍA
Galpón de experimentación EEA Pergamino.
DESCÁRGALO EN PDF
Efectos benéficos de un probiótico en lechones
DESCARGAR BIBLIOGRAFÍA
Galpón de experimentación EEA Pergamino.
GC GP 1,57 1,47
porciNews A Latina Junio 2024 | Efectos benéficos de un probiótico en lechones 69
nutrición

EFECTO DE LA ACTIVIDAD
PROBIÓTICA DEL HIDROLIZADO SACCHAROMYCES CEREVISIAE
EN LOS PARÁMETROS PRODUCTIVOS DE CERDAS LACTANTES
Vicente Bryan Solís-Véliz1 , Manuel Octavio Rivera-Cedeño1 , Ernesto Antonio Hurtado2* y Mario Andrés Carreño-Arteaga2
1Escuela Superior Politécnica Agropecuaria de Manabí, Posgrado de Zootecnia. Calceta, Manabí, Ecuador.
2Escuela Superior Politécnica Agropecuaria de Manabí, carrera de Medicina Veterinaria. Calceta, Manabí, Ecuador. *Correo electrónico: ernestohurta@gmail.com

INTRODUCCIÓN
La producción de cerdos (Sus scrofa domesticus) se ha incrementado a una velocidad vertiginosa a nivel mundial y Ecuador no se escapa de esa realidad; de acuerdo a Lassaletta y col. [19], la producción mundial de carne de cerdo se ha cuadruplicado en los últimos 50 años y se espera que continúe creciendo durante las próximas tres décadas.
porciNews A Latina Junio 2024 | Efecto de la actividad probiótica del hidrolizado Saccharomyces cerevisiae en los parámetros productivos de cerdas lactantes 70 nutrición

En tal sentido, debido a la selección genética para la prolificidad, las cerdas modernas experimentan una gran demanda metabólica de nutrientes para la producción de leche (PL) para satisfacer un gran tamaño de camada [31]; asimismo, el estrés por calor es un factor principal que influye negativamente en el bienestar y la eficiencia productiva de las cerdas en climas cálidos [6, 29].
Es así como ocurre una elevada mortalidad (M) de lechones principalmente en la etapa de lactancia, lo que traduce en pérdidas económicas sustanciales para la industria porcina. Al respecto, Salazar [25] indica que, la mayor parte de la M ocurre durante los primeros tres días de vida de los lechones y su supervivencia está ligada a factores relacionados directamente con

Lechón individual: peso y temperatura de nacimiento
Camada: tamaño y orden de nacimiento
Vitalidad: tiempo que tardan en consumir calostro por primera vez
Los prebióticos y probióticos a base de levadura, se han considerado una alternativa de interés debido a su potencial para modular positivamente la microflora intestinal, lo que puede conducir a una mejor inmunidad, digestión y absorción de nutrientes y rendimiento del crecimiento [11].
1
2
Por lo tanto, los cultivos de levadura se han utilizado ampliamente como: probiótico utilizando una pequeña cantidad de células de levadura vivas; prebiótico con metabolitos de levadura o componentes de la pared celular como aditivos para mejorar el rendimiento [31]. Su uso se ha incrementado en la última década, especialmente después de la prohibición de los antibióticos promotores del crecimiento en Europa [1, 18].
Aunado a esto, la producción y la calidad de la leche no solo proporcionan nutrientes para apoyar el crecimiento de los recién nacidos [28], sino que, en última instancia, afectan el rendimiento del crecimiento y la salud intestinal de las crías [7].
El objetivo de este estudio fue incluir en las dietas de las cerdas, un probiótico hidrolizado (PHZ) de un cultivo de Saccharomyces cerevisiae en la última etapa de la gestación y la lactancia, y, medir el rendimiento posterior de las cerdas y sus crías, junto con los efectos sobre la calidad de la leche de las cerdas.
porciNews A Latina Junio 2024 | Efecto de la actividad probiótica del hidrolizado Saccharomyces cerevisiae en los parámetros productivos de cerdas lactantes 71
nutrición
MATERIALES Y MÉTODOS
UBICACIÓN
El estudio se llevó a cabo en la granja Narcisita, ubicada en la ciudad de El Empalme, parroquia Velasco Ibarra de la provincia del Guayas, Ecuador, con características de una zona climática tropical húmeda.

Se utilizó el PHZ comercial Celmanax® de laboratorio Dimune; cultivo desecado, hidrolizado y extracto de levadura S. cerevisiae, de acuerdo a la descripción del producto.
La selección de 48 cerdas de la línea genética PIC (Camborough, 1050), se realizó sobre la base de 85 días de gestación, entre 1 a 6 partos, con peso promedio 215,6 ± 4,3 kilogramos (kg);
T1: 0 gramos (g)
T2: 3 g
T3: 6 g
ANIMALES, ALIMENTACIÓN Y MANEJO Número de partos/ Bloques
6 6 6 3-4 7 7 7 5-6 3 3 3 Total 16 16 16
Tabla 1. Distribución de animales de acuerdo a los tratamientos bajo estudio.
La inclusión de PHZ (S. cerevisiae) se aplicó directamente en el alimento comercial en los T2 y T3 con la ración del alimento, desde el día 85 de gestación hasta el momento del destete (21 días promedio), que dependió del estado fisiológico y condición corporal de las cerdas, oscilando entre 2,0 a 2,50 kg.
Los lechones fueron pesados al nacimiento (PN) y dentro de las 24 horas (h) de nacidos se descoló, se realizó el descolmillado y se aplicó vía parental en el músculo del cuello 150 miligramos (mg) de hierro a cada lechón.
Igualmente, se obtuvo la ganancia diaria del peso (GdP) de los lechones mediante la relación entre el PN del lechón menos el peso de destete (PD) dividido entre 21 días.
Los animales de los tres grupos se mantuvieron en iguales condiciones de manejo, sanidad y alimentación.
CERDAS GESTANTES
CERDAS LACTANTES
Las cerdas gestantes se ubicaron en el interior de galpón sin ambiente controlado en jaulas independientes. El alimento se suministró en comederos automáticos con agua ad libitum.
Las cerdas lactantes se alojaron en jaulas individuales con sus camadas. El alimento se suministró de manera manual. Y los lechones no recibieron suplementación. Ambos tuvieron agua ad libitum.
Tratamientos T1 T2 T3
1-2
porciNews A Latina Junio 2024 | Efecto de la actividad probiótica del hidrolizado Saccharomyces cerevisiae en los parámetros productivos de cerdas lactantes 72 nutrición
TOMA Y ANÁLISIS DE MUESTRAS DE LECHE
Para la toma de la muestra de leche se realizó 6 y 24 h después del parto un muestreo de las cerdas sometidas al probiótico; recolectando la leche y presionando de forma manual las ubres de las cerdas, posteriormente que se realizó una limpieza con solución de agua yodada, tratando en la medida de disminuir la cantidad de microorganismos patógenos, tal como lo describió Mendoza [20].
La composición de la leche incluyó:

PROTEÍNA % % % %
GRASA LACTOSA SÓLIDOS TOTALES
ANÁLISIS ESTADÍSTICO
Este estudio se realizó bajo un diseño en bloques al azar, con la variable número de partos, el factor de bloqueo (TABLA I); se consideró una cerda o camada como unidad experimental y tratamiento de cultivo de levadura como efecto principal.
El análisis de las variables bajo estudio se realizó a través de la técnica del análisis de la varianza, previamente se comprobó los supuestos normalidad (prueba de Shapiro Wilks y homogeneidad de varianza (prueba de Levene).
Se analizó el número total de: lechones nacidos totales (LNT)
lechones nacidos vivos (LNV)
lechones nacidos muertos (LNM)
mortalidad (M) (%)
PN (g)
mortalidad al destete (MD) (%)
lechones destetados (LD)
PD (kg)
GdP (g)
retorno al celo (RC) (días)
mientras que, a nivel de leche:
PROTEÍNA % % % %
GRASA LACTOSA SÓLIDOS TOTALES
Los promedios de las variables que resultaron significativas fueron comparados por medio de la prueba de LSD de Fischer (P<0,05).
Los análisis estadísticos se realizaron con el software estadístico InfoStat [9].
porciNews A Latina Junio 2024 | Efecto de la actividad probiótica del hidrolizado Saccharomyces cerevisiae en los parámetros productivos de cerdas lactantes 73
nutrición

RESULTADOS Y DISCUSIÓN
INDICADORES DE PARÁMETROS ZOOTÉCNICOS DURANTE EL PERÍODO DEL NACIMIENTO AL DESTETE
En la TABLA 2 se observa el efecto de inclusión del PHZ con cultivo de levadura Saccharomyces cerevisiae desde el final de la gestación hasta la lactancia en el rendimiento de parto de las cerdas; es así como, los indicadores NT y NV resultaron favorables con el complemento del PHZ (P<0,001), alcanzando los mayores promedios cuando se incorporó 6 g (T3).
Estas diferencias pueden estar atribuidas al número de partos que ostentaban las cerdas, y que es un factor predisponente para NT y NV.
Sin embargo, estos resultados permiten inferir que el PHZ en la dieta, desde la gestación tardía hasta el destete pareció ser beneficiosa para las cerdas y el rendimiento de los lechones, lo que podría deberse a una mejor ingesta de alimento, calidad de la leche, estado inmunológico materno y homeostasis microbiana intestinal alterada, tal como lo manifiestan Zhao y col. [30];
todo confluye en un mejor estado de salud de la cerda, producto del equilibrio microbiota en el sistema gastrointestinal, lo cual mejora la absorción de nutrientes.

porciNews A Latina Junio 2024 | Efecto de la actividad probiótica del hidrolizado Saccharomyces cerevisiae en los parámetros productivos de cerdas lactantes 74 nutrición
El aspecto inmunológico es fundamental; así pues, el lechón recién nacido depende de la inmunidad pasiva suministrada por la madre a través del calostro.
Las inmunoglobulinas (Ig) recibidas son capaces de atravesar la pared intestinal durante las primeras horas de vida del lechón [15].
Kim y col. [17] indican que, la alimentación con producto de fermentación de S. cerevisiae (SCFP) (12 y 15 g·día-1 durante la gestación y la lactancia, respectivamente) a las cerdas durante la gestación media y tardía y la lactancia aumentó el aumento de peso de la camada en un 6,9 % (P< 0,01).

Czech y col. [8] reportan un aumento en los LNV y PN cuando la dieta de las cerdas se complementó con productos de pared celular de levadura o manna-oligosacáridos, a partir del día 28 antes del parto.
Sin embargo, Shen y col. [26] refieren de los efectos de la suplementación de levadura durante toda la gestación y la lactancia en el rendimiento de la cerda y la camada, y encontraron que la alimentación con 12 y 15 g·día-1 SCFP durante la gestación y lactancia, respectivamente, a las cerdas no tuvo efecto en el rendimiento reproductivo de las cerdas, pero mejoró el PD de la camada (P=0,068) y GdP de la camada (P=0,084).

Galaz y col. [11] concluyen que la suplementación con levaduras a dietas porcinas durante estrés calórico severo mejora el comportamiento productivo y el estado de salud, y reduce costos del alimento consumido por kg de peso aumentado.
porciNews A Latina Junio 2024 | Efecto de la actividad probiótica del hidrolizado Saccharomyces cerevisiae en los parámetros productivos de cerdas lactantes 75 nutrición
es así como, Chen y col. [5] demuestran que existe un efecto significativo (P<0,05) en la interacción del índice temperatura- humedad × dieta, que influye en el número de LN, LVN, lechones sanos (LS) y PN.
Al respecto, cuando las cerdas fueron alimentadas con levadura viva y extracto de levadura desde el día 110 de gestación hasta el destete, su progenie era más pesada al destete y había aumentado la GdP, consumo diario promedio y peso corporal [4].

En efecto, Kiros y col. [18], con el suministro de levadura durante el período de lactancia mejoró el rendimiento de los lechones.
Además indican que, se modifica la composición de la microbiota del ciego de los lechones dependiente de la dosis empleada.
Asimismo, García y col. [13] refieren que la suplementación con un prototipo liquido de S. cerevisiae en las cerdas lactantes mejora el consumo de alimento
lo que permite a las cerdas mantener las reservas corporales y tener un mejor rendimiento posterior en la recría.
Otro aspecto relevante, es el encontrado por Peng y col. [21] quienes manifiestan que la suplementación con levadura viva (LY) en las dietas maternas
disminuyó el número de lechones nacidos muertos y lechones de peso bajo, mejoró la calidad del calostro y el estado de salud de las cerdas.

Indicadores
Nacidos Totales (n)
± 0,64a 14,04 ± 0,59b 14,56 ± 0,60b 0,0001** Nacidos Vivos (n) 9,92 ± 0,59a 13,21 ± 0,55b
Nacidos Muertos (n)
ns Peso al nacimiento (g)
Muertos (n)
al destete (%)
±
Tabla 2. Efecto de la inclusión del probiótico hidrolizado (Saccharomyces cerevisiae) desde el final de la gestación hasta la lactancia en el rendimiento de parto de las cerdas. a,b: Letras diferentes en la fila difieren estadísticamente, **: Altamente significativo, ns: No significativo.
Tratamientos T1 T2 T3 P-Valor
10,21
13,43 ± 0,54b 0,0004**
0,31
0,54
0,30 1,34
0,30 0,0656
Mortalidad
2,54
2,08 2,54
2,08 5,48
1,95
1296,46
1349,2
33,73 1426,95
36,63
± 0,32
±
±
ns
(%)
±
±
±
0,1167
± 34,37
±
±
0,0639 ns
0,55
0,95
0,96 0,84
0,98
3,08
1,96 4,18
1,84 4,31
1,81
± 1,05
±
0,3210 ns Mortalidad
±
±
±
0,4567 ns
porciNews A Latina Junio 2024 | Efecto de la actividad probiótica del hidrolizado Saccharomyces cerevisiae en los parámetros productivos de cerdas lactantes 76 nutrición
INDICADORES DE PARÁMETROS
ZOOTÉCNICOS DE LAS CERDAS
DURANTE LA LACTANCIA Y POST-CELO
El efecto del PHZ en las cerdas durante el período de lactancia hasta post-celo se observa en la TABLA 3; en tal sentido, se muestra que los T que incluía el PHZ alcanzaron los mayores promedios para lechones destetados y PD (P< 0,01); donde el T3 obtuvo los más altos valores, siendo éstos de 12,41 (± 0,45) y 7,95 (± 0,20), respectivamente.

No obstante, Chance y col. [3] enfatizan que, al incluir levadura viva y un extracto de levadura durante la lactancia de la cerda, el tamaño de la camada, el peso de la camada o el peso promedio de los lechones el día 2 después del parto, el día 10 después del parto o al destete, al igual que M predestete no se ven afectada (P>0,10).
Por otra parte, Zhao y col. [31] revelan que, la GdP de los lechones mejoró en el grupo de cerdas suplementadas con el cultivo de levadura (P=0,036).

Mientras tanto, Bravo y col. [2] concluyen que, la alimentación de cerdas con S. cerevisiae Var. Boulardi (ScVB) CNCM I-1079 mejoró el rendimiento de los lechones durante la lactancia.
Salak-Johnson y col. [24] refieren que, los probióticos pueden mejorar la respuesta inmunitaria innata y adaptativa de las crías de las madres tratadas con probióticos, reduciendo la capacidad de respuesta al estrés de estos lechones ante múltiples factores estresantes.
Así pues, Shen y col. [26] expresan que, la adición del SCFP en las dietas de las cerdas en gestación y lactancia tienen el potencial de mejorar la GdP de la camada durante la lactancia, asociado a la reducción del nitrógeno en urea plasmática, conllevando al mejoramiento de salud madre y como consecuencia la tendencia a mejorar la GdP de la cría.
Esto último, por la mejora de la capacidad antioxidante de los mismos [30].
porciNews A Latina Junio 2024 | Efecto de la actividad probiótica del hidrolizado Saccharomyces cerevisiae en los parámetros productivos de cerdas lactantes 77 nutrición
Indicadores
Lechones Destetados (n) 9,54 ± 0,48a 12,36 ± 0,45b 12,41 ± 0,45b 0,0004**
Peso al Destete (kg) 5,95 ± 0,21a 7,85 ± 0,19b 7,95 ± 0,20b <0,0001**
Ganancia de Peso Diario (g)

± 7,63
± 7,77
± 8,28 0,8113 ns
Días de Retorno al celo (días) 4,16 ± 0,24a 4,40 ± 0,24b 5,18 ± 0,26c 0,0294*
a,b,c: Letras diferentes en la fila difieren estadísticamente, **: Altamente significativo,*: Significativo, ns: No significativo.
Tabla 3. Efecto de la inclusión del probiótico hidrolizado (Saccharomyces cerevisiae) en las cerdas durante la lactancia y post-celo.

Por lo tanto, los derivados de levadura agregado a la dieta de las cerdas durante la gestación aumentan la disponibilidad de calostro y su contenido de energía para los lechones recién nacidos, y también promueve fuentes microbianas maternas beneficiosas para los recién nacidos [14].
Esta respuesta observada en los lechones podría estar relacionada con un mejor estado inmunitario, por los altos valores de IgG [22, 25, 27] y una mejora en la composición de la microflora a nivel del ciego [18].
Con respecto a la variable días de RC, se ve afectada (P=0,029) por la inclusión del PHZ (TABLA 3)
Se muestra que el tratamiento control resultó con menor intervalo entre el destete y celo (4,16 ± 0,24); por otra parte, el T3 alcanzó promedio de 5,18 ± 0,26 días.
Tratamientos T1 T2 T3 P-Valor
225,85
228,43
221,18
porciNews A Latina Junio 2024 | Efecto de la actividad probiótica del hidrolizado Saccharomyces cerevisiae en los parámetros productivos de cerdas lactantes 78 nutrición

Aún cuando Zhao y col. [31] suplementando con cultivo de levadura mejoraron el intervalo entre el destete y el celo de las cerdas, en comparación con las cerdas que no se suplementaron, en valores promedios de 5,16 días en comparación con los 6,12 días (P=0,046).
Finalmente, las diferencias manifestadas entre ambas investigaciones pueden estar asociadas al factor genético e inclusive al índice temperatura-humedad (ITH).
Como se muestra en la TABLA V, la composición de la leche (calostro) no cambió con la inclusión de PHZ (P>0,05), excepto el contenido de la grasa (%) y lactosa (%) que resultaron ser mayor en aquellas cerdas que incluían el PHZ (P<0,05).
Donde T2 con 3 g de inclusión resultó con los mayores promedios (9,36 y 7,74 %), respectivamente.
Esos resultados difieren a los encontrados por Jang y col. [16] quienes, con suplementación directa de levadura viva a las cerdas durante la preñez y la lactancia, reportaron que la levadura viva no tuvo efectos beneficiosos sobre la composición de la leche.
No obstante, Zhang y col. [30] suplementando con levadura y la inclusión de selenio mejoró el contenido de grasa en la leche, tal como se observó en los resultados (TABLA 4).
Indicadores
Proteína (%) 5,17 ± 0,06 5,18 ± 0,05 5,01 ± 0,06 0,0699 ns
Grasa (%) 7,76 ± 0,29a 9,36 ± 0,27b 9,19 ± 0,27b 0,0013**
(%)
Sólidos Tot. (%)

±
a,b: Letras diferentes en la fila difieren estadísticamente, **: Altamente significativo, *: Significativo, ns: No significativo.
Tabla 4. Efecto de la inclusión del probiótico hidrolizado (Saccharomyces cerevisiae) desde el final de la gestación hasta la lactancia sobre la composición de la leche (calostro) en cerdas experimentales.
Tratamientos T1 T2 T3 P-Valor
6,84
Lactosa
5,63
0,52a 0,54 ± 0,30
± 0,48b 0,0248*
19,79
19,17
± 0,58 2,54 ± 2,08
± 0,54 0,7600 ns
porciNews A Latina Junio 2024 | Efecto de la actividad probiótica del hidrolizado Saccharomyces cerevisiae en los parámetros productivos de cerdas lactantes 79
nutrición

Además, Zhao y col. [31] refieren que la composición de la leche en las cerdas con suplemento de cultivo de levadura son probablemente las principales razones para mejorar la GPD individual de los lechones.
Igualmente, Rocha y col. [23] mencionan acerca del suministro dietético S. cerevisiae en la mejora de la PL de las cerdas adultas y el rendimiento de sus camadas, así como el contenido de proteína y materia seca de la leche en las cerdas más jóvenes en condiciones climáticas tropicales húmedas.
En efecto, derivados de levadura agregado a la dieta de las cerdas durante la gestación aumenta la disponibilidad de calostro y su contenido de energía para los lechones recién nacidos, y también promueve fuentes microbianas maternas beneficiosas para los recién nacidos [4].

Por otra parte, García y col. [12] concluyen que, mejora el consumo de alimento y el crecimiento de la camada sin afectar la PL ni la calidad del calostro.

porciNews A Latina Junio 2024 | Efecto de la actividad probiótica del hidrolizado Saccharomyces cerevisiae en los parámetros productivos de cerdas lactantes 80 nutrición
De este modo, Plante y col. [22] destacan que, cuando se alimentó tanto a la cerda (al final de la gestación y lactación) como a los lechones (1 semana antes de las 4 semanas posteriores al destete), mejoraron las ganancias de peso y la eficiencia alimenticia posteriores al destete.
Además, observaron tendencias a un mayor contenido de proteína y gamma globulina en la leche de las cerdas tratadas y concluyen que los efectos beneficiosos sobre los rendimientos posteriores al destete podrían atribuirse a una mayor inmunidad a través de la leche de la cerda y/o a la presencia de levadura seca activa en el dieta de los lechones.
Asimismo, Chen y col. [5] reportan que el ITH afecta negativamente la composición de la leche, probablemente debido a la disminución de la ingesta de alimento durante la lactancia, mientras que la suplementación dietética de SCFP no tuvo un impacto beneficioso en la composición del calostro y la leche.

CONCLUSIONES
Estos resultados implican la utilización de PHZ (S. cerevisiae) en la dieta a razón de 3 y 6 g en cerdas durante gestación tardía (85-114 días) y lactación (0-21 días), por su efecto potencial como suplemento alimenticio.

Finalmente, el uso estratégico del PHZ (S. cerevisiae) mejora significativamente el estado de salud de las cerdas y los lechones lactantes, así como los parámetros de crecimiento de los lechones; dado al efecto ejercido en la grasa y lactosa de la leche.
Efecto de la actividad probiótica del hidrolizado Saccharomyces cerevisiae en los parámetros productivos de cerdas lactantes
DESCÁRGALO EN PDF
DESCARGAR BIBLIOGRAFÍA
porciNews A Latina Junio 2024 | Efecto de la actividad probiótica del hidrolizado Saccharomyces cerevisiae en los parámetros productivos de cerdas lactantes 81
nutrición

Una visión técnica e innovadora del sector porcino en América Latina... ¡A un click de distancia! /porcinewslatam ¡Suscríbete! www.porcinews.com








































































































 Gráfico
Gráfico

DESCÁRGALO EN PDF
Efectos benéficos de un probiótico en lechones
DESCARGAR BIBLIOGRAFÍA
Galpón de experimentación EEA Pergamino.
DESCÁRGALO EN PDF
Efectos benéficos de un probiótico en lechones
DESCARGAR BIBLIOGRAFÍA
Galpón de experimentación EEA Pergamino.























